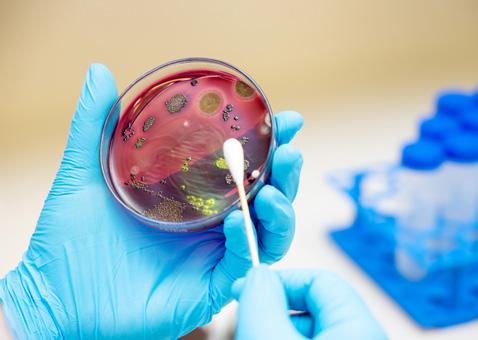

![]()









At the end of every year, trainers from across Europe gather together for the annual European Trainers’ Federation (ETF) Annual General Meeting.
In December 2024, the meeting was hosted by the Irish Racehorse Trainers Association and delegates representing the major European racing nations gathered at The Curragh to discuss the key issues facing trainers.
The role of the ETF is to listen to opinion from different representatives and use the meeting as a sounding board for its engagement with the likes of the European Horse Network which provides vital support on any equine related issue, presented to the European Parliament.
The Federation also lobbies individual authorities and provides opinion on regulatory matters based on the opinions of racehorse trainers from across the European continent.
At our December meeting, we learned about decisions being made in Germany - on the whim of activist groups who have zero interaction with, or understanding of, the racing industry. But have seemingly successfully lobbied their government to introduce a study which could potentially result in far reaching changes being placed on the German racing industry in years to come.
It transpires that the government wants to look at a raft of legislation which would restrict the age as to when a racehorse can enter into training and exercise. The government isn’t listening to or understanding the racing industry and before any laws or regulations are implemented it wants to do a quantitative study on training by purchasing a group of thoroughbreds from Hungary which are likely to be trained outside of Germany! So how can this study ever be relevant to the German racing and breeding industry?
Anyone who knows anything about German racing will know that German bred horses are some of the soundest horses anywhere in the world. So why not use German bred horses, trained in Germany by German trainers for the study? Surely this study is fundamentally floored before it has started.
As we enter a new year, we (as an industry) should take pride in the fact that more is being achieved than ever before in the understanding of ‘best practice’ for the racehorses under our care and groups like the ETF need to challenge and educate those who are promoting studies such as the one being put forward in Germany.
So, in the next issue of this magazine, we will circulate a questionnaire to readers which will look, in depth, at the lengths trainers go to, to achieve ‘best practice’. The results of the questionnaire will be shared with policy makers across Europe to give them a better understanding of what goes into the training of a racehorse and hopefully not jump to ill conceived conclusions before understanding the actual subject. Afterall, knowledge is power - ignorance is bliss.
Wherever your racing takes you this winter - good luck!







to download our current digital editions and access back issues of both European and North American Trainer
06 TopSpec Trainer of the Quarter
This quarter, Lissa Oliver features Ralph Beckett with Starlust who came from a near last-to-first run to land the Breeders’ Cup Turf Sprint to cap an unbelievable season for the Hampshire-based trainer.
08 Gavin Cromwell - the leading dual-purpose trainer
Daragh Ó Conchúir profiles Irishman Gavin Cromwell as to why he is no longer a farrier but a multiple Grade 1 and Cheltenham Festival-winning trainer.
24 Tips for feeding horses prone to gastric ulcers
Spillers’ senior nutritionist, Sarah Nelson, delves into the art and science of feeding horses prone to gastric ulcers.
30 The state of jump racing around the world
Paull Khan reports on the state of jump racing and measures to increase the appeal of jump racing around the world.
38 A herbal approach to digestive health
Catherine Rudenko examines how herbs and plants can be used as digestive aids for performance horses and horses in training.
46 Is SDF tendinopathy a “professional condition” in the jumping racehorse?
Jean-Baptiste Pavard reviews the latest research on tendon injuries and gives helpful advice on prevention and management.
54 Bacterial gut diversity
Alysen Miller reviews a new study that shows the clearest link yet between gut health and athletic performance.
62 Why embryos can fail
Jackie Zions interviews Dr. Tracey Chenier on how we can improve the odds for successful breeding.
68 Beneath their hooves
Virginia Lisco looks at the development and sustainability of different racing surfaces.
72 Thoroughbred genetic research
Holly Robilliard and Cassie Fraser discuss the principles of genetic research and its use and implementation within the thoroughbred racing world.



ROAD
FEBRUARY 26,

Kempton
FEBRUARY 28, 2025
PATTON STAKES
Dundalk Stadium - IRELAND
APRIL 5, 2025
UAE DERBY (G2)
Meydan Racecourse - UAE

Louisville, Kentucky
May 2, 2025 - Edgewood Stakes (G2T)
$500,000
3 YO Fillies | 1 and 1/16m
May 3, 2025 - American turf (G1T)
$500,000
3 YO | 1 and 1/16m
May 3, 2025 - Twin spires Turf Sprint (G2T)
$500,000
3 YO AND UP | 5 and 1/2F
May 3, 2025 - Old Forester Turf Classic (G1T)
$1,000,000
4 YO and up | 1 and 1/8m

new kent, virginia
August 9, 2025 - Arlington million (G1t)
$1,000,000 3 YO and up | 1 and 1/4m
August 9, 2025 - beverly d (G2t)
$500,000
3 YO and up f&M | 1 and 3/16m
August 9, 2025 - Secretariat (G2t)
$500,000
3 YO and up | 1 m
Editorial Director/Publisher
Giles Anderson
Sub-Editor
Nico Jeeves
Design/Production
Damian Browning
Advert Production
Lauren Godfray
Circulation/Website
Lauren Godfray
Advertising Sales
Giles Anderson
Cover Photograph
David Betts Photography
Trainer magazine is published by Anderson & Co Publishing Ltd.
This magazine is distributed for free to all ETF members. Editorial views expressed are not necessarily those of the ETF. Additional copies can be purchased for £8.95 (ex P&P). No part of this publication may be reproduced in any format without the prior written permission of the publisher.
Printed in the European Union
For all editorial and advertising queries please contact:
Anderson & Co. Publishing
Tel: +44 (0) 1380 816777
Fax: +44 (0) 1380 816778
email: info@trainermagazine.com www.trainermagazine.com
Issue 88
Jean-Baptiste Pavard graduated from the University of Liege (Belgium) in 2023. Having been raised in Normandy in France, he developed a passion for horses from an early age. He undertook varied placements in Europe, Australia and in New Zealand before completing an equine hospital internship at Goulburn Valley Equine Hospital (Australia). His main area of interest is surgery and lameness with a special interest in thoroughbred racehorses. JeanBaptiste came back to France and is now a vet at Equicare located at the heart of Chantilly which focuses on all aspects of sports and performance in thoroughbred racehorses.
Jackie Bellamy-Zions is communications manager at Equine Guelph for the past ten years, Jackie has over 30 years of experience in the horse industry in the capacity of coach, trainer, stable manager, competitor, judge and journalist.
Cassie Fraser, a native Vermonter, is the content writer for Etalon Equine Genetics. Her background in veterinary medicine, horse training and marketing helps her bridge the gap between equestrians and genetic testing.
Paull Khan, PhD. is an international horseracing consultant. He is a member of the Executive Council of the International Federation of Horseracing Authorities (the global peak body for thoroughbred racing) and Secretary-General of the European and Mediterranean Horseracing Federation. His other clients include the British Horseracing Board. Previously, Dr Khan held many senior roles at Weatherbys, including Banking Director and Racing Director.
Virginia Lisco, born and based in Italy and studied International and Diplomatic Sciences. She has always been passionate about horses and a few years ago discovered the world of horse racing which has since become her world. She has worked in some Italian stables, and subsequently sought to explore all areas related to racing. Her ambition is to thoroughly understand all aspects concerning the industry and the promotion of horse welfare.
Alysen Miller is a writer, editor and producer based in London. She has written about racing for publications including The Sunday Times. She launched and produced CNN International’s first dedicated horseracing magazine show, Winning Post. She has ridden on the Flat as an amateur and currently competes in eventing on her retrained racehorse, Southfork.
Sarah Nelson is a senior nutritionist at Spillers and is responsible for the technical management of all Spillers’ products, including feed formulation. She has been a part of the Spillers’ team since 2009, and she has advised horse owners, trainers and vets on all aspects of practical nutrition. Her current role involves translating key scientific messages into practical advice for owners, as well as providing nutritional consultations for clinical cases.
Daragh Ó Conchúir is a native of Rinn Ó gCuanach, Co Waterford and is a freelance media professional with more than 30 years’ experience of writing and broadcasting in sport, covering a multitude of disciplines and roles for a variety of national and regional organisations. An author of four books, nominee as HWPA Racing Writer of the Year (for Irish and UK racing writers) and reporter for TG4’s acclaimed Rásaí Beo racing coverage.
Lissa Oliver lives in Co. Kildare, Ireland and is a regular contributor to The Irish Field and the Australian magazine, Racetrack. Lissa is also the author of several collections of short stories and two novels.
Holly Robilliard is a published author and scientist, with a passion for equine health. For the past two years she has worked at Etalon Equine Genetics, helping to revolutionise the way we breed and train horses.
Catherine Rudenko is an independent registered nutritionist with a focus on thoroughbreds. Based in the UK Catherine has worked in the USA, Europe and Asia with trainers and studs creating feeds and feeding plans customised to their needs and climate. With a keen interest in education and research Catherine works with professional bodies and universities to promote knowledge of nutrition and its importance in the management of thoroughbreds and other breeds.

AIMS and OBJECTIVES of the ETF:
AIMS andOBJECTIVES of theETF:
a) To represent theinterests of allmembertrainers’ associationsinEurope.
a) To represent the interests of all member trainers’ associations in Europe.
b) To liaise with politicaland administrative bodies on behalf of European trainers.
b) To liaise with political and administrative bodies on behalf of European trainers.
c) To exchange information between members for the benefit of European trainers.
c) To exchange information betweenmembers forthe benefitofEuropeantrainers.
d) To provide a network of contacts to assist each member to develop its policy and services to member trainers.
d) To provide anetwork of contacts to assist each member to developits policyand services to member trainers.

Chairmanship:
GuyHeymans (B elgium)
CHAIRMANSHIP: Gavin Hernon (France)
tel: +33 (0)7 87 16 02 48 email: contact@aedg.fr
Tel:+32(0)495389140
Email: heymans1@telenet.be

Vice Chairmanship:
NicolasClément(France)
Tel:+33(0)344572539
Fax:+33(0)344575885
Email:entraineurs.de.galop@wanadoo.fr
VICE CHAIRMANSHIP: Paul Johnson (United Kingdom)
tel: +44 (0) 1488 71719 email: p.johnson@racehorsetrainers.org
Mrs Živa Prunk
Tel: +38640669918
Email: ziva.prunk@gmail.com

ITALY
Joseph Vana
Tel:+42(0)602429629
Ottavio Di Paolo
Email: horova@velka-chuchle.cz
tel: +39 328 355 95 81 email: ottaviodipaolo@gmail.com
Aggeliki Amitsis
Tel:302299081332+
Email: angieamitsis@yahoo.com

SWEDEN
GERMANY
Jessica Long
ErikaMäder
Tel:+49(0)2151594911
email: jplong@live.se
Fax:+49(0)2151590542
Email: trainer-und-jockeys@netcologne.de

Vice Chairmanship:
Christianvon derRecke (Germany)
Tel:+49(02254)845314
Fax:+49(02254)845315
Email: recke@t-online.de
VICE CHAIRMANSHIP: Christian von der Recke (Germany)
tel: +49 171 542 5050 email: recke@t-online.de
Mr Botond Kovács
Email: botond.kovacs@kincsempark.hu

BELGIUM
Agostino Affe
Email: affegaloppo@gmail.com
Guy Heymans
tel: +32 (0) 495389140 email: heymans1@telenet.be
Geert van Kempen
Mobile: +31 (0)6 204 02 830
Email: renstalvankempen@hotmail.com

GERMANY
Erika Mäder
Are Hyldmo
Mobile: +47 984 16 712
tel: +49 (0) 2151594911
Email: arehyldmo@hotmail.com
www.trainersfederation.eu

Treasu ship:
MichaelGrassick(Ireland)
TREASURERSHIP:
Tel:+353(0)45522981
Mobile:+353(0)872588770
Fax:+353(0)45522982
Feidhlim Cunningham (Ireland)
Email:office@irta.ie
tel: +353 (0) 45522981 email: office@irta.ie
Rupert Arnold
Tel:+44(0)148871719
Fax:+44(0)148873005
Email: r.arnold@racehorsetrainers.org

RUSSIA
NETHERLANDS
Olga Polushkina
Email:p120186@yandex.ru
Birkje Hoorens Van Heyningen
tel: +31 (0) 250 930 016
email: birkjehvh@gmail.com
Jaroslav Brecka
Email: jaroslav.brecka@gmail.com

NORWAY
SWEDEN
Tom Lühnenschloss
CarolineMalmborg
Email: caroline@stallmalmborg.se
mobile: +47 (0) 46445345
email: lynet3108@yahoo.no

The TopSpec Trainer of the Quarter award has been won by Ralph Beckett. Beckett and his team will receive £1,000 worth of TopSpec feed, supplements and additives as well as a consultation with one of their senior nutritionists.
WORDS: LISSA OLIVER PHOTOGRAPHY: ALEX EVERS & BILL DENVER/ECLIPSE SPORTSWIRE
When Starlust came from a near last-to-first run to land the Breeders’ Cup Turf Sprint in a thrilling finish, trainer Ralph Beckett was one of the few unsurprised by the 34-1 winner. It hadn’t been a longterm plan, but with the three-year-old colt’s liking for a flat track, as highlighted by his fondness for York, the team at Kimpton Down Stables in Hampshire were fairly confident.
Beckett first took out his licence in 1999 and now has a team of 180 at the stateof-the-art yard in the idyllic Hampshire countryside near Andover, sending out 18 Gr.1 winners. Kimpton Down has
three all-weather gallops, including a 1600m straight woodchip, and 35 acres of downland grass, that have been used as gallops for over a century. Beckett also installed a treadmill, enabling horses to remain in full work without being ridden, as well as being excellent for rehabilitating horses returning from injury. There are also 30 acres of turnout paddocks, used all year round thanks to the chalk base.
Starlust’s 2024 Breeders’ Cup win came only a month after Bluestocking had won the Prix de l’Arc de Triomphe for Beckett, but for Starlust this was a first success at top-level. After a busy juvenile campaign the colt had run a creditable third to Big
Evs in the Breeders’ Cup Juvenile Turf Sprint in 2023, so was no stranger to an end-of-year trip to America.
“As in all of these things, and after the end of a long year, the main concern for us was to concentrate on the horse’s wellbeing, particularly after his traumatic experience in the Prix de l’Abbaye,” says Beckett, when Starlust was badly hampered in the final 200m and collided with the rail. “As much as anything it was about getting his head right. We took him away for a day, the day out being the most important thing rather than the work, and when he came home he was happy and we knew he was in good form.”

The draw is all-important for the l’Abbaye, but Starlust had the luck of the draw at Del Mar. “He has shown a distinct liking for York and a flat track suits him very well, so that was particularly relevant,” Beckett points out.
He acknowledges the work also put in by his team at the historic Kimpton Down Stables, particularly his Assistant Trainer Joe Tuite, Head Man and Assistant Gary Plasted, and Travelling Head Grooms Richard Arnold and Emma Wilkinson.

“Emma does most of the work when they fly and has been with me a long time and knows the routine very well, she’s very experienced. At home, Joe Tuite and Gary Plasted are hugely experienced and Joao Cardoso, Barn Manager, knows the horse really well.
“Starlust is a really tough horse and that shone through at Del Mar. He’s not had a break all year and has been at it since Meydan in January. He’ll definitely have a holiday now.”

•
•
•
• Efficient
• Healthy
•
• Efficient
•





WORDS: DARAGH Ó CONCHÚIR PHOTOGRAPHY: DAVID BETTS PHOTOGRAPHY, GALOPPFOTO.DE, TATTERSALLS
avin Cromwell has just arrived at Goresbridge for the Point-to-Point and National Hunt Horses-in-Training Sale. This is off-Broadway fare, with a toppriced lot of €62,000 taken home by Charles Byrnes. Only a handful of Irish trainers are active. Most of the stock is bound for Britain.
GIt offers a glimpse as to why Cromwell is no longer a farrier but a multiple Grade 1 and Cheltenham Festivalwinning trainer, with three victories in Prestbury Park’s signature championship contests.
He may now be officially categorised in a so-called Big Four in the Irish jumps game but he is bemused by the association with Messrs Mullins, Elliott and de Bromhead given their relative rolls of honour. His market remains primarily at far lower levels.
Three days previously, Cromwell had acquired three yearlings at the Tattersalls December Yearling Sale. Lest one has forgotten, the Meath man has saddled group winners on the flat too, at two of the most exalted venues of that sphere, ParisLongchamp and Ascot. He has enjoyed the thrill of Royal success at the latter course twice.
Princess Yaiza scored in the Prix de Royallieu in 2018, nine months after Raz De Maree delivered in the Welsh Grand National. Raz de Maree was a 13-year-old gelding galloping over nearly 3m6f on heavy ground and jumping 18 fences (four were omitted). About three and a half years later, two-year-old filly Quick Suzy scorched to glory in the 5f Queen Mary Stakes on good-to-firm going at Royal Ascot.
The three yearlings were bought for an accumulated £108,000, a Ghaiyyath colt being the most expensive at £40,000.
After speaking to me, Cromwell adds another trio to his burgeoning army, costing a grand total of €49,000.
The €25,000 for Aspurofthemoment is his largest single outlay.
His success and the horses he has bought over these few days offer a snapshot of Gavin Cromwell’s talents, his all-inclusive approach to training and sourcing, his ambition and his tireless endeavour. There is no pigeonholing this guy. Juveniles, veterans, handicappers, elite performers, over obstacles or on the level. You have a horse with some ability, he will get it to win.

And while he has had some significant support from JP McManus in particular over jumps and Lindsay Laroche on the flat, both relationships were cemented by his initial and continuing success for them. After selling a horse to Qatar Racing last year, he will have a couple of more in their colours in 2025. These affiliations developed from the foundation stone of the entire operation: sourcing stock cheaply as most of his owners do not have deep pockets. If they are good, they are often sold to people that do.
What being in Goresbridge tells us is that Gavin Cromwell is always on it, to use modern sporting parlance. He does not switch off. And the results speak for themselves.
How recently was Gavin Cromwell still a farrier? Many will be surprised to hear that he only finished “four or five years ago.” That’s after he had become a Cheltenham Champion Hurdle winner.
The 50-year-old is now a six-time Festival victor at Prestbury Park, with half of those successes coming in championship races, Flooring Porter’s Stayers’ Hurdle double arriving in the wake of Espoir D’Allen’s Champion Hurdle triumph in 2019.
His tally of winners over jumps and on the flat continues to rise, while his countless cross-channel raids have yielded 14 winners at a 23% clip last season over jumps and an even better percentage of 5/20 since the start of 2023 in the summer code.
This has been achieved within a clear business strategy that focuses on a sound financial footing while marrying that with a philosophy based on ambition, and a development of leadership techniques that have proven more essential as the operation has grown from his early days on a 14-acre greenfield site, to the 150 stables and state-of-the-art facilities on 80 acres at Danestown. That brings more staff, more owners, more suppliers. More demands.


So you develop a team around you. The likes of Garvan Donnelly, who is now his right-hand man. Keith Donoghue, the jockey who helped revitalise Tiger Roll and Labaik in his days working for Cromwell’s former housemate, Gordon Elliott. Race planner, Troy Cullen. Kevin and Anna Ross, brought on board to oversee the purchase of more flat horses, many of which have been sold at a considerable profit.
Being among the aforementioned quartet excluded from some races by Horse Racing Ireland as a strategy to increase opportunities for the rest of the trainers came as a shock. Not least because he has not had a Grade 1 winner in Ireland since







Flooring Porter announced himself a star of the future in the Christmas Hurdle at Leopardstown four years ago. That was his fourth top-flight triumph and that tally has been doubled across the water at Cheltenham and Aintree.
For context, Willie Mullins saddled a world record 39 last season alone. Cromwell should really be heralded as a poster boy for what is possible in what some observers have argued is an unproductive, overly polarised environment, unconducive to fresh blood breaking through.
While he would love a yard of Grade 1 horses and dreams of registering a maiden Group 1, most of his stock comprises handicappers. Therefore, the selling angle on the flat is a vital element of the operation. The paradox of that model is he sees the negative impact that has had on the depth of the flat game, as well as the National Hunt.
It all makes for a riveting conversation.
Given that there isn’t a category of race Cromwell does not have a horse or an owner for, talent acquisition is a round-the-clock consideration. And it is one of the areas he has had to outsource because of his expansion.
“Kevin and Anna Ross have been helping to buy the yearlings for the last season, and this season. That’s working out great,” he says and with good cause.
Among the selections last year are dual group-placed Fiery Lucy, who finished her season a slightly unlucky three-length fourth to Lake Victoria in the Breeders’ Cup Juvenile Fillies Turf at Del Mar. Mighty Eriu was sold to Qatar Racing after finishing second on debut and went on to be runner-up in the Queen Mary, Cromwell’s worst result from his three juvenile runners at Royal Ascot. An Chorr Dubh was sold to America for six figures after winning on debut at Gowran Park. That trio cost less than €80,000 between them.
Diego Ventura was more expensive, relatively, at €72,000 but that was at the Tattersalls Breeze-Up Sale in May. He won on debut two months later under Cromwell’s go-to flat pilot, Gary Carroll, and was promptly sold to Wathnan Racing, transferring to the tutelage of Hamad Al Jehani in Newmarket.
“I’ve always bought all my own horses up to this but it’s very hard to find time to do everything, and then, of course, to try and find someone that you trust, so Kevin and Anna have been great for the flat horses.
“I’m taking a run down here to Goresbridge today and it’s the lesser point-to-point horses but we have lots of lesser orders. Predominantly, it’s the lesser horses that we have.
“You’re constantly trying to think outside the box and trying to buy value, and trying to buy a horse that could potentially turn out to be a decent horse. You would always be trying to buy an unlucky horse. A horse that was second or third maybe, in some of those maidens, and the winner maybe made three or four hundred thousand. And maybe he had three or four runs, and it didn’t happen for him. Maybe he could have a fall mixed into the form.”
It brings to mind Emmet Mullins revealing in this publication last year that he always had an eye on strong finishers in point-to-point maidens. He prefers a horse galloping through the line in third to a winner hanging on. The market can miss a horse like that. When you don’t have a huge reservoir of funding, you have to be smart, identify a gap that few, if any, have noticed or have interest in.
“The other thing you have to do is, you have to take a chance. I would buy some of these horses on spec; find them and bring them home. I bought Will The Wise last year on spec, £95,000. It was as much money as I’ve ever spent on spec on a horse. But thankfully, I got someone to buy him.


“I suppose when things are going well, you can have the confidence to do that. You’ll find someone. It’s a little bit easier for me to say that than it is for a smaller trainer that has a handful of horses and no access to any owners. It is difficult but listen, I was that person one time. I remember buying a horse in Newmarket and he stood me 20 grand. I couldn’t find anybody for him, and I had to sell him to another trainer.”
But he kept going back. After stints with Dessie Hughes and Paul Kellaway, and at Flemington Racecourse, while he chased a dream of being a jockey, he took out his licence to train in 2005, having learned his trade as a farrier. Dodder Walk was his first winner over jumps, in Cork on April 7, 2007. Five Two broke the duck on the flat at Dundalk on November 26, 2010. Balrath Hope bagged the Ulster Oaks two years later and Sretaw delivered a big pot with the Irish Cambridgeshire in 2014. Elusive Ivy won the JLT Handicap Hurdle and Mallards In Flight the Glencarraig Lady Handicap Chase.
By now, his services as a farrier were much in demand, with the high-flying Elliott a major client. As he notes himself, it is only until very recently that being the man that shod 2015 Gold Cup winner, Don Cossack wasn’t what people tended to mention when his name came up.




Having started with a barn for eight horses to train as a hobby, with an apartment above it that he lived in, Cromwell added a second for 13. The recession gazumped all progress but he would not be deterred. Picking up horses and making contacts brought better results. Further barns were built, housing 25, then 30 and then 50. An isolation yard was added also.
The five-furlong straight, uphill woodchip gallop has worked splendidly with the flat juveniles ready, and while his jumpers will use it too, they are generally worked on the round, deep sand gallop complete with speedometer.
While the share in prize money is considerable, it is moving the flat horses through the international market that really greases the wheels and facilitates the improvement of the amenities. It is a delicate balance, when you are hungry to climb the ladder and improve the quality of your string, but pragmatism ensures you are still in business next year.
“We’ve got plenty of yearlings this year and sold plenty of twoyear-olds. I suppose it’s a business model that we’re buying them with the view to trading them. I have a few Flat owners, the likes of Lindsay LaRoche, who owned Princess Yaiza and Snellen, who won at Royal Ascot. Those horses are bred to race and bought to race. So that’s slightly different to the rest of the business model.





“We sold Mighty Eriu this year to Qatar and she stayed with us for a little bit. She went to Royal Ascot and I think we’re going to potentially have a couple of Qatar horses for next season. We have one three year old here at the moment for them.
“So some will stay in training, and then others are in training to be sold, whether they’re sold to existing owners, or maybe someone could buy them and they stay at the yard, remains to be seen. But it’s a business model, and it’s been working nicely. We’ve bought plenty of yearlings now for next season and hopefully they will work out.”
The prize money in Australia, Hong Kong and America puts a value, in particular, on a band of horse that cannot be replicated in Europe. So capitalising on big offers will always make sense but it does mean that the pool is thinning, in both codes, with many of those flat horses having previously transitioned into jump athletes.
“I actually didn’t go to Newmarket Horses-in-Training Sale this year or last year. It’s so hard to buy those three year olds to go hurdling. It’s too expensive for what they are, for what we want them for. The Australian market is too good and lots of those international markets.
“We sent a few to Goffs Horses-in-Training Sale. They were looked at numerous times, and they all sold. They had won a few, but they were only at a level. We had two jump horses at the sale, and they never got looked at once. It’s a world market (on the flat), and they went to all different countries, and there’s no problem selling them. It’s a great trade. But it means we can’t buy off the flat to go jumping or to have as good dual-purpose horses.”
Attending sales are about more than going with a shopping list.
“The lads who are getting on are the lads you’ll meet at the sales. You have to be buying your horses all the time. And sure you don’t know who you’re gonna meet. I seldom go to a sale that I don’t come home with a horse, whether I met someone and I got the horse to train, or I bought him.”
The future dividend of networking can be significant too because relationships are at the core of anything that thrives. Gavin Cromwell Racing is no different.
“You spend your whole time trying to surround yourself with good people and if you can keep adding to that, it makes everything work better, and it makes life a lot easier. Someone said to me one day, ‘You spend all your time trying to make yourself redundant.’
“The system is there, and the people are there to implement it. You’ve the 3Ds: decide, delegate and disappear. And I think sometimes, the hardest part of that is to disappear. But if you decide and you delegate, there’s no point doing them unless you disappear. You delegate, you have to pass on the responsibility, and the only way you’ll pass that on is to disappear. And if it’s not done right then, well then you’ve to go back to the start again. But if you’ve decided and you’ve delegated, you have to pass out the responsibility, and you have to do it with confidence. That’s what makes everybody grow.”
A really clever person knows what they do not know. And they go about ensuring that they acquire those skillsets or surround themselves with people that possess them. That’s how it has been with the management of people and Cromwell’s leadership.
“I suppose you learn from other people. I learned an awful lot from some of my owners, who are obviously very good in business, and chat to them. They pass on a lot.”
2,771







There have been some personnel additions in recent years that have been pivotal in the upward surge.
“Garvan Donnelly is my head lad/assistant trainer. He’s been a game changer for me, heading for three years now. He was head lad with Arthur Moor back in the day when Arthur was champion trainer. He was training himself. Thankfully, he came to work for us. I’ve Troy Cullen helping with the race planning and he’s been brilliant.
“Keith Donoghue has been a huge asset to the yard. Apart from being a brilliant rider, he’s a huge help to me with the day-to-day stuff, with the training and making plans. I don’t think there’s too many would disagree, he’s one of the best in the country. We’re very lucky that he’s with us.”
It is easy to identify now when the first real significant upswing in fortunes occurred. As happens so often, breeder, Gus Bourke only put Jer’s Girl into training because he could not sell her. It was a different ball game after she won a Listed juvenile hurdle in Aintree under Richard Johnson. Bourke was ready to cash in.
On the day she was declared to run in the Grade 1 Mares’ Novice Hurdle at Fairyhouse at the end of March 2016, JP McManus completed the deal. She got the new association off to the perfect start, nine days after her trainer had gone to Cheltenham to see Don Cossack and Bryan Cooper gallop to glory in the Gold Cup.
Cromwell had resisted the temptation to bring his stable star across the water and was rewarded, pitching the four-year-old in against the older novices to provide him with his maiden Grade 1 success. They repeated the trick the following month, this time beating the young boys too in cantering to a ten-length triumph in the Champion Novice Hurdle. All Barry Geraghty had to do was steer.










It prompted McManus to reward him with an increased patronage that has continued to this day. The first youngster they sent that summer happened to be Espoir D’Allen. He was the first fiveyear-old to win the Champion Hurdle in 15 years and his winning margin of 15 lengths was the widest in the history of the race.
The son of Voix Du Nord never ran again, killed after a freak accident coming back from the gallops as he began his buildup to the following season. It was a devastating blow but it was absorbed, even if it still makes Cromwell wince.
Flooring Porter – owned by a four-man syndicate from Galway, though the numbers in the parade ring when he wins suggest there are countless more tethered to his fortunes – went backto-back in Stayers’ Hurdles in 2020 and 2021 and had the Grand National in his sights after a sensational victory in the Kerry National at Listowel, only for injury to intervene.
These are the vicissitudes of the equine world.
If Jer’s Girl catapulted him to a different plane, her conditioner struggles to identify when he felt that he was a 24-hour trainer.

“It was very gradual. I don’t think there was any one day that I woke up and said, ‘I can actually be a full-time trainer for the rest of me days.’ I started out as a full-time farrier and a part-time trainer, and then I kind of became more a trainer than a farrier but was clinging on to the farrier job for a number of years because I still hadn’t the confidence that this was going to stay working as well as it was, or I was going to grow any better than it was.
“I suppose eventually I just didn’t have the time to do any shoeing. It got to the stage that I couldn’t shoe my own.”
So when his last apprentice had completed his term, Cromwell officially left his profession of more than 20 years to one side. That apprentice is now his farrier.
So maybe that was when he finally made it, though as befitting the prototype of the Irishman absolutely terrified with the notion of anyone thinking they were running away themselves, it is not a term he would ever, EVER use to describe where he stands in the overall firmament.








In a way, the HRI announcement that he would be precluded from running horses in 60 races, along with Mullins, Elliott and Henry de Bromhead was a PR boon, placing him officially among a grouping of the best in the jumping game.
While he has brought about incredible growth, and the quantity of winners has increased exponentially, hitting a career high 72 over jumps in Ireland last season, in terms of prize money and calibre, he is in the same sort of sphere as Joseph O’Brien, who operates a far smaller jumps team, and only edged ahead of the Carriganóg handler into fourth on the trainers’ table for the first time in 2023/24.
Indeed, since Cromwell’s last Grade 1 on native shores secured by Flooring Porter four years ago, Shark Hanlon, Noel Meade (2), Paddy Corkery, Barry Connell (2), O’Brien, Emmet Mullins, Martin Brassil (3), Jimmy Mangan (2) have scored at the highest level in Ireland.
Given his journey, no one is more aware of the challenges faced by the so-called small man battling for even a tiny piece of the pie. Being penalised for navigating those challenges so well seems bizarre but Cromwell points out that it isn’t really about the trainers.
“The point that everybody is missing is that they’re punishing the owner. I have so many small owners with low-budget horses.

I’m here in Goresbridge today and if I come out with a horse, it’s going to be a horse that’s maybe placed in a point to point or placed somewhere. It’s low level stuff. Why are you punishing that man? Or the group of lads that put a syndicate together and I have lots of syndicates.
“I’ve 150 stables because I’ve chosen to keep building these stables, and keep going to these sales, and keep buying the horses and trying to find an owner for them. I’m hungry enough and work hard to do that. I’ll put my hand up at the sales and the bill will be at home before I’ve left. It doesn’t mean I have a yard full of superstars or big owners.
“I have great owners, many in it for the first time. I have a couple of horses you would be hoping might be competitive in a Grade 1. That’s it. There’s some really good trainers out there who choose not to have 150 jumpers there and they have access to really big owners and more Grade 1 horses and fair play to them.”
He believes that providing more opportunities for lower-grade horses, particularly on the high-profile days, where the prize money is better and the RTÉ or TG4 cameras are in town, is the way to help Irish trainers, and particularly racing’s key constituents.
“I feel they need to change stuff with the system to get the horses competitive earlier and to look after the bottom end of it.













Have more racing for the lower end. And have an 80-102, or as they’re all in tens from next year, an 80-110 handicap hurdle at a big festival, like they have the 102 hurdle on Thyestes day. Have a low-grade handicap or some type of race for the small man that Willie or Gordon are not going to have horses for. There’s a good chance I would have something in it because I do have them horses, but give the small man a day out on the big day.
“There’s a huge emphasis on the trainer and the last person to get a mention is the owner, if he gets a mention. It’s the Willie Mullins camp, the Gordon Elliott camp and they have lots of different owners. There should be far more emphasis on the owner. The owner is number one.”
It’s a good point, well made.
The truth is, Cromwell just wants to get on with doing what he has always done. Train winners at whatever level is suited to the animals he is responsible for. And while he would like more top-tier horses, he acknowledges that the quality has improved significantly along with the numbers.
“We don’t have too many empty stables anymore. When you’re doing the entries now there’s, there’s not as many to stick into the 80-95s as there used to be, so the quality is getting better. And sure, I think if you were to ask any trainer, it’s not more numbers that you want, it’s better quality. But sometimes you have to go through the numbers to try and find them. And we cater at all levels, and all sorts of budgets.”
Inothewayurthinkin was one of two McManus homebred full-siblings to win for Cromwell at Cheltenham last March –Limerick Lace being the other in the Mares’ Chase – and the facile Kim Muir victor, who followed up with a convincing triumph in the Grade 1 Mildmay Novices’ Chase at Aintree, resumed his campaign this term in the John Durkan Chase last month.
Considered by many to be the best chase ever run in Ireland, it was certainly a case of being plunged into the deep end and while well beaten by Fact To File, there were positives.
“He jumped very well. It was the big concern. Last year he was a bit scratchy. When he gained ground on the flat he’d lose it at a jump, just jumping a bit high and slow. Two and a half miles in a properly run Grade 1, his jumping held up. He wants further and he got a bit tired but I’d be happy enough.
“He has an entry for (the Savills Chase) at Christmas there, and he’s up to three miles there and at that stage, we’ll know whether we’re good enough (for a tilt at the Gold Cup) or not.”
Only By Night, Sixandahalf, Hello Neighbour and Will The Wise are among the younger talents for which various dreams of more exalted targets are alive, though the real tests are still to come. Limerick Lace, Vanillier, Brides Hill and Stumptown are just some of the more established ones that will have lofty targets as the season reaches its crescendo.
Either way, Gavin Cromwell’s eye will always be on the ball in a sport and industry that operates 365 days a year. Training winners, no matter the standard, is the goal.
So far, so very good.

All my horses are on NUTRI-GARD, I think it’s a great product. I have found that it helps to keep my horses relaxed, which is so important for the sprinters. NUTRI-GARD helps to keep the weight on them, their stomachs are settled, and their minds are good.
DANNY MURPHY

NUTRI-GARD is a scientifically advanced gut supplement formulated to support stomach and hindgut health. Containing 12 key ingredients including prebiotics, postbiotics, and B-vitamins, it is designed to support the entire digestive tract.
Also features:
• Prebiotics
• B-vitamins
• Pectin
• L-Threonine
• DL-Methionine
• Oat fibre
FOR Digestive health




Risk factors for squamous or ‘non-glandular’ ulcers are well documented and include low forage diets and long periods without eating, diets high in non-structural carbohydrate (NSC) or ‘starch and sugar’, intensive exercise and stress, as well as prolonged periods of stabling and travelling. While some risks may be unavoidable for racehorses in training, diet is one that can be influenced relatively easily.
This article outlines some of the science and provides some practical advice on the nutritional management of horses prone to non-glandular ulcers. While glandular ulcers may be less responsive to changes in diet, the same nutritional management is generally recommended for both glandular and non-glandular ulcers.
Evidence that diet makes a difference
Research published by Luthersson et al (2019) was the first to show that changes in diet can reduce the recurrence of non-glandular ulcers following veterinary treatment. In this 10-week trial, fifty-eight race/ competition horses were paired according to their workload, management and gastric ulcer score (non-glandular ulcers graded 0-4). One horse from each pair continued with their normal diet while the other had their normal ‘hard feed’ replaced with the trial diet which was divided into three equal meals. Horses with grade 3 and grade 4 ulcers were also treated with the recommended dose of omeprazole for four weeks. All horses were scoped at the start of the trial, immediately after omeprazole treatment had finished and 6 weeks after treatment had stopped.
The majority of horses improved as a result of omeprazole treatment regardless of diet. Diet had no effect on grade 2 ulcers. At the end of the study, gastric ulcer scores in the horses that were fed the trial diet were not significantly better or worse than in horses that were not fed the trial diet. Overall, gastric ulcer scores in horses that were fed the trial diet remained improved 6 weeks after treatment had stopped. Six weeks after treatment had stopped, gastric ulcers scores had worsened in the majority of horses that remained on their normal feed so that overall, there was no difference between pre and post treatment scores.
Importantly, this research shows that changes in diet can help to reduce the risk of gastric ulcers recurring after veterinary treatment, even if other changes in management are not possible. There was also no apparent long-term benefit of omeprazole treatment alone, highlighting the importance of other strategies in the long-term management of horses prone to gastric ulcers. As this study only evaluated changes in ‘hard feed’, it is possible that greater improvements could have been achieved if changes to forage were also made.
Regular turnout often isn’t possible for horses in training and while the risk of gastric ulcers generally seems lower in horses at pasture, recent research carried out in Iceland by Luthersson et al (2022) has highlighted this may not always be the case.
In Iceland, horses typically live out at pasture, often in large herds and if stabled, they are generally fed a high forage, low starch and low sugar diet. While Icelandic horses do get gastric ulcers, it’s been suggested that the over-all incidence is low.
The aim of this study was to investigate the incidence of gastric ulcers in Icelandic horses moving from pasture into light work. Prior to the study, all horses had lived out in large herds for their entire adult lives (age range 3-7 years), had never been in work and were fed supplementary forage in winter months only.
All horses were scoped within two weeks of being removed from pasture (prior to starting ‘training’) and were scoped again after approximately 8 weeks of being stabled and doing light work. Most horses were only fed forage during the training period, but 11 were given very small amounts of soaked sugar beet and 3 were given a small amount of commercially produced feed. However, in all cases, starch and sugar intake from ‘hard feed’ was equivalent to less 250g per meal for a 500kg horse which is well within the current recommendations for horses prone to gastric ulcers.
Approximately 72% of horses had non-glandular ulcers (grade 2 or above) at scope 1. The prevalence and severity of gastric ulcers improved after eight weeks of stabling and light work - approximately 25% of horses had non-glandular ulcers (grade 2 or above) at scope 2. Horses given forage three times per day as opposed to twice per day were almost 18 times more likely to improve! Over-all, the incidence of glandular ulcers decreased from 47% to approximately 41%
The high prevalence and severity of non-glandular ulcers at the start of the study, and the subsequent improvement following the training period was unexpected. Not only is this research an important reminder that horses at pasture are still at risk of gastric ulcers, it highlights the importance of regular forage provision.

Forage is critical for mental wellbeing and digestive health in all horses but sometimes receives less attention than ‘hard/ concentrate’ feed, particularly for performance horses. When it comes to reducing the risk of gastric ulcers, one of the main benefits is promoting chewing.
Saliva provides a natural buffer to stomach acid but unlike people, horses only produce saliva when they chew, which is why long periods without eating increase stomach acidity. In one study, the risk of non-glandular ulcers was found to be approximately 4 times higher in horses left for more than 6 hours without forage, although the risk may be greater during the day.
Research by Husted et al (2009) found gastric pH drops in the early hours of the morning, even in horses with free access to forage. Not only do horses generally stop eating/ grazing for a period of time during the early hours of the morning, they are normally less active at night, reducing the risk of gastric splashing.
It should also be remembered that forage is a source of fuel –even average hay fed at the minimum recommended amount may provide close to 45% of the published energy requirement for a horse in heavy exercise. Forage analysis can be a useful tool, especially if you can source a consistent supply.
Routine analysis normally includes measuring / calculating the water, energy and protein content, as well as providing an indication of how digestible the fibre is - more digestible forages yield greater amounts of energy and can help to reduce the reliance on feed.
Ideally all horses, including racehorses in training should be provided with as much forage as they will eat. However large amounts of bucket feed, intense training and stress can affect appetite so voluntary intake (how much is eaten) should be monitored wherever possible.
In practice, this means weighing the amount of forage that’s provided, as well as any that is left in a 24-hour period.
Ideally, total daily forage intake should not be restricted to less than 1.5% bodyweight per day on a dry matter basis, although an absolute minimum of 1.25% bodyweight (dry matter) is considered acceptable for performance horses, including racehorses in heavy training.
On an ‘as fed basis’ (the amount of forage you need to weigh out), this typically equates to approximately (for a 500kg horse without grazing):
• 9kg of hay if it is to be fed dry or steamed (or an absolute minimum of 7.5kg)
• 11-12kg of haylage - based on a dry matter of 65-70% (or an absolute minimum of 9-11kg)
The difference in feeding rates can cause confusion but essentially, even unsoaked hay contains some water and the water doesn’t count towards the horse’s forage intake.

The fermentation of starch by bacteria in the stomach results in the production of volatile fatty acids which in conjunction with a low pH (acidic environment), increases the risk of ulcers forming. Current advice, which is based on published research, is to restrict nonstructural carbohydrate (NSC) or ‘starch and sugar’ intake from ‘bucket feed’ to less than 1g per kilogram of bodyweight per meal and ideally less than 2g per kilogram of bodyweight per day. For a 500kg horse, this is equivalent to:
• Less than 500g per meal
• Ideally less than 1kg per day
Traditional racing feeds are based on whole cereal grains and as a result, are high in starch. By utilising oil and sources of highly digestible fibre such as sugar beet and soya hulls, feed manufacturers can reduce the reliance on cereal starch without compromising energy delivery.
There are several reasons why horses should be fed small meals but one that’s of particular importance to managing the risk of gastric ulcers is reducing the amount of starch and sugar consumed in each meal. Large meals may also delay gastric emptying and in turn, lead to increased fermentation of starch in the stomach, especially if cereal based. Restrict total feed intake to a maximum of 2kg per meal which is equivalent to approximately 1 Stubbs scoop of cubes.


Alfalfa’s high protein and calcium content is thought to help buffer acid.

The horse’s stomach produces acid continuously (although at variable rate). Exercise increases abdominal pressure, causing acid to ‘splash’ onto the stomach lining in the non-glandular region where it increases the risk of ulcers forming. Exercise may also increase acid production. Feeding short chopped fibre helps to prevent ‘gastric splashing’ by forming a protective ‘fibre mat’ on top of the contents of the stomach and may be of increased benefit to horses on restricted forage diets. Current advice is to feed 2 litres of short chopped fibre by volume – equivalent to 1 Stubbs scoop – within the 30 minutes prior to exercise. Ideally choose a fibre containing alfalfa as the high protein and calcium content is thought to help buffer acid.

Supplements are often an attractive option, with owners and trainers from various disciplines reporting benefits. Unfortunately, scientific evidence is currently limited with some studies producing conflicting results which means specific recommendations regarding the optimum blend of ingredients and recommended daily intakes have not been established.
However, ‘ingredients’ that may help to support gastric health include pectin and lecithin, omega 3 fatty acids, fenugreek, threonine, liquorice and maerl, a marine derived source of bioavailable calcium. But don’t forget, there are some important safety considerations, both for horse health and mitigating the risk of prohibited substances.
• Supplements should never be used as an alternative to veterinary treatment or an appropriate diet.
• Beware of bold claims – if it sounds too good to be true it probably is!
• It is illegal for manufacturers to claim products can cure, prevent or treat gastric ulcers. Words like ‘soothe’ and ‘improve’ are also prohibited. While bold or illegal claims do not automatically mean a supplement is unsafe, it does raise questions over the company’s ethics.
• Speak to a nutrition advisor before feeding supplements containing added vitamins and minerals as some can be harmful (or even toxic) if oversupplied.
• Avoid supplements (and feeds) containing added iron.
• Be cautious of supplements containing iodine, including naturally occurring sources such as seaweed.
• Ensure the total diet provides no more than 1mg selenium per 100kg bodyweight (5mg per day for a 500kg horse).
• Natural does not always equal safe – avoid herbs of unknown origin.
• In the UK, use only BETA® NOPS (British Equestrian Trade Association, Naturally Occurring Prohibited Substances) approved feeds and supplements.
• Only use supplements produced by an authorised feed manufacturer (supplements are classified as feeds in the UK and the EU and regulated by the same legislation). Approval numbers must be included on the label but knowing what to look out for can be tricky. That said, any supplement carrying the BETA® EGUS approval mark will have been produced by an authorised manufacturer.





Although they are by no means the only suitable option, you can be assured that feeds carrying the BETA® EGUS approval mark have been through a rigorous independent review process to ensure:
• The combined starch and sugar content is less than 25% for high energy feeds and less than 20% for low-medium energy feeds
• They provide less than 1g of starch and sugar (combined) per kilogram bodyweight per meal when fed as recommended
• No inaccurate or medicinal claims are made on the packaging or in marketing materials
• The feed is correctly labelled
• It fulfils the nutrient specification – this includes independent laboratory analysis
Full references for scientific research available on request.









hat state of health is jump racing really in?
WFor someone living in Britain, for example, the picture is a little confusing. On the plus side, interest levels in the sport relative to the flat seem never to have been higher – of the top British races by betting turnover, almost all are over obstacles. And no festival, Royal Ascot included, generates more anticipation and excitement than does Cheltenham. Then one considers Ireland and the merciless pummelling, which the Brits have become accustomed to, of the home team by Irish-trained horses at that very Festival. And France: you won’t find a topflight jumps card where the commentator’s mastery of French pronunciation will not be put to the test – such is the prevalence of French-bred imports.
But then, on the darker side of the coin, one cannot fail to register increasing societal unease. A growing unwillingness to accept the unavoidable reality of injuries and fatalities, however rare their occurrence. And views being expressed that these headwinds are not only serious – they may be terminal, with venerable trainers
opining that jump racing in Britain will not outlive them. And we are aware of the swingeing contraction of jump racing in Australia, which gives those existential fears more weight.
So, your columnist set out on a journey of discovery – to try to find out the true state of health of jump racing globally.
The first thing I was struck by is how rare a bird jump racing is, globally speaking. There are vast tracts of this planet on which the sport simply does not exist. More troubling yet, in several parts of the world there are memories of a sport that once existed but that has now perished.
Take Canada. Ross McKague of the Canadian Graded Stakes Committee sets out the picture starkly. “We have never had, do not currently have, nor are there any plans for, any organized jump races in Canada.”
Similarly in South Africa. “Apart from one or two amateur jump races on the inside of the race course in the Eastern Cape at the now defunct Arlington Race course”, Arnold Hyde, Racing Control Executive at the National Horseracing Authority there explains, “I am not aware of jump races in an official capacity
taking place here. I guess that there has not been a culture for jump racing in South Africa and with our dwindling horse population (hopefully with the latest import/export developments the trend is reversed), I cannot see this changing anytime soon”.
How about South America, then? Ignacio Pavlovsky, IFHA Technical Advisor for that continent, recalls there having been racing in Chile once upon a distant time. His research reveals that the last steeplechase was held there in 1986.
So where, outside Europe, is this elusive creature to be found? The USA for one – but restricted to a ribbon of States in the East of the nation. We have mentioned Australia, where, within recent years, the sport has ceased in both Tasmania and South Australia and is only now to be found in Victoria. Then there’s New Zealand and Japan. And that, unless anyone corrects me, is just about it.
What is the scale of jump racing in these non-European countries, and how has it shifted in recent decades? Taking as our simple metric the number of jump races staged, we can see that Japan has virtually flat-lined over the past 20 years. USA, meanwhile, has seen a 20% decline, while New Zealand’s programme has all but halved and Australia’s has worse than halved.
Over that period, there has been a remarkable consistency in what has happened to average field sizes. In America, they have reduced by 13%, in New Zealand by 14% and in Australia by 15%, indicating that the pool of jump horses is contracting at a faster rate than the number of contests on offer. The average jump race in Australia attracts 8.2 runners; that in New Zealand 7.8 and that in the States just 6.5. Reducing field sizes is, in fact, a scourge of jump racing affecting virtually all of the world’s jumping nations.
And what of the future? Hearteningly, two recent reviews, the first in New Zealand and the second in Australia, have come down in favour of the continuation of the sport. The latter took place against the backdrop of calls from the local RSPCA for the closure of the sport in Victoria, following the deaths of three horses at the August meet in Ballarat.
September’s announcement from RV stated that “Due to the increase in fatal incidents across the 2024 jumps racing season, this year’s review will go beyond the standard process. A broader, whole-of-business approach will be adopted to analyse a broad range of metrics….The report and recommendations will consider the future viability of jumps racing in Victoria, and/or what further changes can be made to improve the safety record of the sport”.
RV’s Chaiman, Tim Eddy added: “The safety record across the 2024 jumps racing season was unacceptable and the events of the final meeting at Ballarat were heartbreaking for all involved in the Victorian jumps racing community”.
Last month’s report linked jumping’s reprieve to a raft of safety measures, including the cessation of jumps racing at certain tracks, a contraction of the season in the quest for safe ground and increased oversight on safety compliance.
Meanwhile, just over the Tasman Sea, a very similar exercise has recently concluded. And if one needed any more evidence of the existential nature of these deliberations, consider this early sentence from the review’s executive summary:
“The scope of the review is to evaluate the future of jumps racing by examining scenarios in which it either continues or is discontinued”.
Again, the review came down in favour of continuation and prompted this joyous headline to an article by respected journalist Michael Guerin: ‘Jumps racing saved in New Zealand with bold new changes ahead’.
Noteworthy was the difference in tone and apparent motivation for the two studies. Whereas, in Victoria’s, horse welfare was front and centre, in New Zealand the focus was more on such aspects as revenue, employment and jump racing’s role as a second career for flat racers. Its approach to the welfare issue was muted: “It is well documented that jumps racing carries higher risks than flat racing, to both horses and jockeys. The figures however did not suggest to the Panel that jumps racing should be discontinued, but the Panel did agree that any additional safety measures should be identified and implemented”. The report gave a nod to “avoiding firm track conditions early in the jumps season” and noted that “even those who supported the continuation of jumps identified a concern about use of the whip during the races, especially at the end of the races after the last jump…when horses are tired”. Its main recommendations, however, centred on programming changes, promotional initiatives to raise the profile of jockeys, and various measures for their sourcing, (including, intriguingly, “a recruitment and licensing program to streamline the readiness of UK riders for racing in New Zealand”).
For Guerin, this emphasis is reflective of broader public attitudes in New Zealand where, he observes “many have farm ties and most city people probably don’t watch jumps racing as it is no longer in Auckland”.
Japanese jump racing is battling twin concerns of declining betting revenue and dwindling jockey numbers. The Japan Racing Association’s Takahiro Uno, Chair of the Asian Pattern Committee notes that its jump races were recently moved, as a result, from the major tracks to smaller venues. But there is a desire to protect the rich history of jumping – Japan’s premier jump race, the Nakayama Daishogai, is not far away from its centenary. Already, an apprentice system which is agnostic as to the age of the apprentice has been introduced, to incentivise flat riders to make the transition and a return of some jump races to the big metropolitan venues is under consideration.
Let us return home, to Europe. A survey of EMHF members revealed that jump racing can be found in no fewer than 13 of them. That’s the good news. The less good news is that decline and contraction is evident virtually across the board, and in two countries - Austria and Norway - jump racing has died out within the last 20 years.
In Germany, the downswing is precipitous.
Despite a 93% reduction in jump races since 2004, field sizes have plummeted to less than 4.5 runners. To Rudiger Schmanns, Racing Direktor at Deutscher Galopp the sport is in its last throes. What does he envisage in the next 10 years? “No races. No, riders, no horses and further animal welfare pressure”.
The picture in Italy is brighter – but not much.
In 2004, 728 individual horses started over the jumps; today that number is 212. Twenty years ago, one could enjoy jumping at 15 Italian tracks. Now, there is just Pisa, Trevisa and Merano left. The lastnamed remains a gem amongst European jumps courses, but is heavily propped up by incoming foreign-trained runners, mainly from the Czech Republic. Around half of Merano’s prize money goes abroad, and around half of that to the powerful Czech stable of Scuderia Aichner and Josef Vana jnr.
And, turning to Czech Republic on our European round-up, we detect the first green shoots of optimism.
Decreased <50%
Decreased >50%
Ceased
While a reduction in scale is still apparent, it is far less pronounced than in the earlier countries. And the above tells but half the story, since, as has been noted, Czech-trained runners ply their trade in neighbouring countries with great success. Martina Krejci, General Secretary of the Czech Jockey Club observes: “Very many Czech trainers and owners start in jump races abroad. For example, this weekend in Wroclav (Poland), the

Crystal Cup runners were almost all Czech”. Krejci anticipates a bounce-back will take place starting next year, with race numbers returning to their levels of 10 and 20 years ago. One of the biggest impediments to growth, though, is the dearth of jockeys.
It is as well to consider the Central European countries as a region, as well as individual territories, such is the level of international traffic of runners.


Polish statistics are distorted somewhat by the fact that, in the early part of this century, a number of jump races for halfbreds were additionally run. These then ceased, and were supplanted with thoroughbred races, which drew liberally for their runners from neighbouring countries, such as Czech Republic. Notwithstanding this quirk, Polish jump racing, if not in rude health, is certainly faring better than most.

Sweden now flies the Scandinavian jump racing flag alone. The jumps are a distant memory in Denmark and the last hurdle race in Norway took place in 2022. Swedish jumping’s future is itself under intense scrutiny, explains Dennis Madsen, Racing Director of the Swedish Horseracing Authority, following the betting operator’s devastating decision no longer to take bets on this code of racing.
For Madsen, though, jump racing’s problems are very largely replicated on the flat in Sweden, and he detects a frightening decline in horseracing the world over which he feels is both inexorable and inevitable. “Yes”, he concedes, “Cheltenham and Ascot and the Melbourne Cup still sell out, but these are merely the biggest icebergs, which will melt the slowest. The smaller countries will be erased before the bigger countries – but the bigger countries are melting as well”.
One can find jumping in Belgium, Channel Isles, Hungary, Slovakia and Switzerland, in some of which it is hanging on doggedly, but the scale of activity in these countries is even tinier – none runs more than 20 jump races annually.
Which leaves Britain, Ireland and France. The sheer scale of the dominance of the ‘big three’, and particularly of Britain, is vividly apparent from this chart. Between them, they account for over 90% of the world’s jump races. Nearly 8,000 jump races are run each year around the world and nearly half of these take place in Britain.
So, when considering the overall health of the jumps, most of our attention must be paid to this triumvirate.
France has seen just a modest 10% reduction in its jump races since 2004, where it is staged on 93 tracks today, compared with 123 tracks then. But the number of starts has fallen far faster, by more than one quarter, meaning that field sizes have gone from 10.4 down to 8.4.
Among the causes of this decline, Henri Pouret, Chief Operating Officer at France Galop cites the rise in French-breds


being exported, a reduction in racecourses on security grounds due to a lack of volunteer staff and a shortage of jump jockeys, especially amateurs. However, the code remains an important part of the French racing product: “Jump racing and breeding are key in the horse racing landscape in France”, says Pouret. “It still represents one third of the races organised in France and of our different runners. There is a plan to restore Auteuil Racecourse which is the flagship of jump racing in France”.
“The main factor likely to influence the scale of jump racing in France over the coming years, will be public perception and social license to operate regarding falls and fatalities”.
To invigorate the sport, Pouret would welcome the development of pony racing over jumps.
Ireland’s jumps industry is showing considerable resilience. The number of races has actually increased, but individual horses competing in those races and the aggregate number of starts are both down by over 10%, leading to average fields of a still healthy 11.5, compared with a whopping 13.8 twenty years ago. However, the metrics have improved in the most recent decade.
Jason Morris, Director of Strategy at Horse Racing Ireland, provides the context: “Ireland is in a more positive position than many jurisdictions as jump racing has grown over the past 10 years in line with HRI’s strategic objective to become the global leader. The number of races and runners has increased while we have been able to maintain a very competitive average field size of 11.5 runners per race. Irish runners are consistently winning the majority of races at the Cheltenham Festival and an Irish trainer, Willie Mullins, was crowned British champion trainer for the 2023/24 jumps season. An attractive race programme, strong prize money, well attended race meetings and the continued success of Irish-trained runners are incentivising many international owners to have their jumps horses based in Ireland, while the Irish point-to-point sector continues to provide an invaluable nursery for developing young horses”.
“Our intention is that jumps racing will continue to grow in Ireland over the next 10 and indeed 20 years”.
“The biggest influencing factor and threat to Irish jumps racing is the potential decline of jumps racing in Britain given its importance as an export market for Irish horses and the symbiotic racing and breeding relationship between the two countries. A strong British jumps sector is vital for Irish racing”.
“In terms of invigorating jumps racing, there are concerns about the availability of sufficient horses going forwards and HRI is working on initiatives with the Irish Thoroughbred Breeders Association to ensure the continuing production of quality Irish-breds, including earlier participation on the racecourse for jumps-bred horses. The concentration of success in a shrinking number of very powerful yards is another area for focus. While we celebrate the success of our top trainers, we want to ensure that the grass roots continue to grow as well and that there is a strong pyramid supporting the upper echelons. We will therefore be looking at race planning measures to provide more opportunities for smaller trainers and owners to be competitive. Finally, equine welfare is very much at the forefront of everything HRI does, and we work very closely with the Irish Horseracing Regulatory Board to ensure the highest standards of veterinary care and injury risk prevention”.
And a not dissimilar picture is apparent in the world’s jump racing capital, Britain. Again, there are more races today – 10% more over two decades. But, as we have seen in so many countries, the jump horse population and its preparedness to compete has fallen, by some 12%. The pressure on field sizes is more acute in Britain than in Ireland, having fallen from 10.2 (2004) to 8.2 today.
Let us turn to Richard Wayman, the British Horseracing Authority’s Director of Racing and Betting, for a perspective on these bald statistics.

“Although our numbers have remained relatively stable in more recent years, since 2004 there has been a 6.5% decline in the number of horses running at least once over Jumps during the course of the year”.
“There are many factors that will have contributed to that downward trend, not least the expansion and improvement of the all-weather programme on the Flat through the winter. It is only since 2006 that we have had floodlit meetings routinely staged throughout the core Jumps season and we believe that this change has had an impact on the number of horses running over obstacles.”
“We’ve also seen an increase in the number of Flat horses being sold to continue their careers overseas and that too has also meant fewer horses switching codes. The days of Jump trainers buying large numbers of horses off the Flat at the Horses in Training Sales in the autumn has become an increasingly distant memory as more and more horses are purchased to continue their Flat racing career elsewhere”.
“There have been some changes in the make-up of racehorse owners that, in all likelihood, have worked against Jumping. The number of sole owners has declined, with there being an increase in syndicates and racing clubs. Whilst some of those groups, of course, own horses over Jumps, the lower risk of injuries, the prospect of the horses being able to run more often and the potential to pick up more prize money has almost certainly worked in favour of the Flat. Indeed, it is interesting to see an increasing number of Jumps trainers evolving their own business models to include training Flat horses”.
“More generally, the difficult economic climate will have had a downward impact on racehorse ownership, as will the increasing urbanisation of society meaning that fewer people are involved with horses generally, again something that will have particularly worked against Jump racing”.
How would Wayman anticipate these numbers will look in 10 and 20 years’ time?

3336 3797 3651
HORSES 9080 8495 8488 STARTS 33982 31221 29943
“Although some of our numbers have been under pressure over the past decade or two, Jump racing remains incredibly popular with fans of the sport. The top 15 races in Britain for generating betting turnover all take place over Jumps. In addition, 37 of the top 50 betting races are also over obstacles”.
“Of the three race meetings that cut through into mainstream media in Britain – namely the Cheltenham Festival, the Grand National meeting, and Royal Ascot – two take place over Jumps. Our terrestrial broadcaster reports that their viewing figures are at their highest through the Jumps season”.
“Jump racing remains a hugely popular and much-loved sport that can thrive in the years ahead. That doesn’t mean that it will return to the levels of 20 years ago as we have to accept that the world has changed. However, with help from a mix of short- and longer-term measures, we believe that Jump racing can grow, and indeed thrive, over the course of the next decade and beyond”.
What would he like to see happen to invigorate Jump racing?
“A variety of measures, rather than one silver bullet, will all need to play a part in supporting our participants and racecourses to ensure that we collectively deliver a robust and vibrant sport in the years to come”.
“This will involve supporting the supply chain of Jump horses, continuing to invest in the mares’ programme and providing financial incentives to support the breeding of quality Jumping stock. It will require learning lessons about what has worked elsewhere and understanding whether those could be successfully applied in Britain, for example the earlier development of Jump horses such as in France, or the Novice Chase programme in Ireland”.
“We must make the ownership of Jump horses as attractive as possible. As well as investing in the overall experience, at a time of rising costs, making the financial equation more enticing for owners will be key to supporting the quality and quantity of our Jump horses”.
“We have some brilliant Jumps trainers and, again, introducing steps that will assist them in attracting investment from owners, in particular building upon our increased investment that is being made into the Novice programme for both hurdlers and chasers, will be vital”.
“The race programme also has a role to play in ensuring that we can deliver an effective development pathway which provides promising young horses with the opportunities to help them fulfil their potential and provide the sport with its future stars”.
“And, of course, the development of exciting equine stars is critical to ensuring that Jump racing remains an attractive proposition for fans and customers, both new and existing. As a broad, overarching and final point, it obviously remains vital to maintain a strong and constant focus on all possible measures to improve the welfare and safety of our horses and riders, together with ensuring we provide a sport that is consistently more competitive and compelling at all levels”.
What, then, might we say in answer to our opening question?
Well, first, it must be conceded that we have simply taken jump racing’s pulse – a full medical examination would be necessary to make secure pronouncements. But it might be safe to conclude the following.
• Jump racing, while present in fewer locations than in the past, is still to be found in seventeen jurisdictions spread across four continents, and staged at over 200 racetracks.
• Nearly half of all jump races are run in Britain, with over 90% in Britain, Ireland or France.
• In the past 20 years, the number of jump races has fallen, but only by 3.5%, from a little over 8,000 races to a little under that figure.
• The pool of horses taking part has shrunk significantly, by around 18%, from over 23,000 to around 19,000.
• Further, these horses are tending to run less slightly frequently, with aggregate starts in jump races falling by over 20%. The average jumper now makes 3.55 starts per season, rather than 3.7.
• Field sizes have come under pressure world-wide, as a consequence. There are, on average, two fewer horses in each jumps race – 8.6 compared with 10.6 in 2004.




“I’ve noticed my horses move better in Fairfax Saddles” - Nicky Henderson OBE

Jonbon, winner of the Tingle Creek Chase 2023 and 2024

The use of herbs and plant extracts to manage digestive ailments in other species is well documented. Whilst equine specific research is somewhat limited, some research is available and shows promising results. The principle common to traditional herbal medicines, whichever system is adopted, is that the patient is considered as a whole. This includes taking into account age, current level of vitality, emotional state or personality, along with environmental challenges.



The use of herbs and plant extracts to manage digestive ailments in other species is well documented. Whilst equine specific research is somewhat limited, some research is available and shows promising results. The principle common to traditional herbal medicines, whichever system is adopted, is that the patient is considered as a whole. This includes taking into account age, current level of vitality, emotional state or personality, along with environmental challenges.
The digestive system is considered of primary importance as digestive health influences other aspects of health within the body. That traditional view is one that is now upheld firmly in modern science, as we become increasingly aware of the influence of gut health on other body systems. Within the human food sector there now exists a multitude of supplements targeting gut function, changing the microbiome and promoting various health benefits derived from such changes.
Plants present an opportunity to do more to manage digestive health for horses in training but supply and safety are significant challenges. Not all herbs are approved for use in racing as they contain substances that are banned in racing, for example ephedrine commonly found in Indian snakeroot, or synephrine that is often found in bitter orange cultivars. Just because a herb is available online and marketed for equine does not mean it is safe to use in racing. There is also the consideration of supply chain, as the global herbal market does not operate with the racing industry in mind. Whilst many herbs are themselves safe for use in racing by their action or composition, the supply chain may expose them to contamination with herbs or other materials containing banned substances. It is therefore essential only to use herbs and blends from companies operating under codes of practice, such as BETA NOPS who are assessing and managing the risk of contamination with naturally occurring prohibited substances (NOPS).

The information in the article discusses some of the plants most commonly used or better evidenced for their effects on aspects of digestive health. Research is other species unless specifically stating equine. The information below is designed to provide an introduction to herbs commonly used for digestive health, the majority of which are available through reputable brands.
Whilst horses are out of training there is scope for use of a broader range of herbs, although again supply should be carefully considered. Withdrawal times for herbs are largely not known, so if using a plant with an active substance on the prohibited list careful consideration should be given as to its use and when it would be reasonable to return a horse to training. The best practice would be to avoid this risk and only consider using herbal supplements appropriate for horses in training.
From ultra low to traditional levels
A range of options to suit different degrees of gastric sensitivity
All designed to fuel performance and recovery






Herbs noted for antiulcer or antacid effects
• Tumeric (Curcuma longa)
Traditionally used for symptoms including inflammation, gastritis and gastric ulcers. In a study looking at the effect of curcuma longa extract the effects noted were reduced gastric acid secretion and protection against gastric mucosal lesions.1 Effect noted as from blocking of H2 histamine receptors.
• Chamomile (Matricaria recutita)
One of the most widely studied herbs. Well known for its antioxidant and inflammatory properties. It has also been studied for its effects on management of diarrhoea and gastric ulcers.2 Effect likely from antioxidant properties.
• Milk Thistle (Silybum marianum)
Milk thistle has been reported as having protective effects against ulceration through its positive effects on mucosa.
• Fenugreek Seeds (Trigonella foenum-graceum)
Traditionally used for a variety of digestive disorders. Fenugreek seeds have been studied and compared with omeprazole for their protective effects against ulcers. In one study the soluble gel extract from fenugreek seeds was found to be as effective as omeprazole for experimentally induced ulcers. 3
• Licorice (Glycyrrhiza glabra)
Well known for its anti-ulcer properties in humans and documented as an effective antacid. Research has shown that licorice used in donkeys with glandular ulcers induced by phenylbutazone was effective at reducing ulcer severity. Licorice was also effective at preventing associated phenylbutazone induced hypoglycaemia.4
There are other herbs also with reported ulcer benefits mostly from a healing perspective including corydalis, gotu kola and bacopa.


Herbs are most often prescribed in combination, as a cocktail of herbs will provide more than one mode of action, and will take into consideration other aspects of a state of disease.
Herbal combinations for ulcers within equine research is limited but some studies exist for marketed products. An Italian company has shown efficacy of a combination of minerals and herbs, namely fenugreek, licorice aloe vera and fleawort extract at reducing ulcer severity score of thoroughbreds in training.5
Another commercial preparation trialled in humans based on bitter candytuft, melissa leaf matricaria flower, caraway fruit, peppermint leaf, angelica root, milk thistle, elan-dine herb and licorice root was proven effective at lowering gastric acidity and inhibiting serum gastrin levels.6
Although gastric ulcers are the most common concern for horses the remainder of the digestive tract is equally challenged by the training environment and needs for high energy feeds. Herbs are often used, and well documented, for the management of human digestive disorders. Whilst there is not always a direct equine equivalent the similarities in conditions makes a herbal approach an interesting consideration.
• Boswellia (Boswellia serrata)
A potent anti-inflammatory herb with evidence for use in management of inflammatory bowel disease (IBD) and Crohn’s disease. In both cases research proving Boswelia as effective as medication in some studies.
• Chamomile (Matricaria recuita)
A herb with multiple benefits, including carminative effects. Widely used for any inflammatory condition of the bowel and gastrointestinal spasms.
Be prepared for your best

performance lighting
Equilume Performance Lighting harnesses the benefits of natural sunlight to improve fertility, performance and well-being for your breeding stock including maiden mares, barren mares, pregnant mares and stallions and acilitate flexible management and reduce costs associated with stabling horses for early season reproductive success.
Earlier Ovulations Regulated Estrous Cycles
Increased Fertility
Optimized Gestation Lengths*
Improved Post-Foaling Fertility*
Improved Maturation In Utero
Stronger Foals At Birth
Optimized milk production & quality colostrum
*Studies show mares foal on time, with earlier foal heat ovulations.
Increased Total Sperm Numbers*
Increased Fertility & Libido
Higher Testosterone Levels*
*Published scientific results using Equilume Stable Lights

So-called because ancient civilisations knew it was the finest feed for horses. We call it alfalfa; rich in natural vitamins and minerals, horses look their best when fed alfalfa.



This group of herbs is used to lubricate and protect digestive tract membranes. Some herbs in this group are also in the antiulcerogenic group, highlighting that herbs often carry multiple benefits across categories. Their primary mode of action comes from mucilaginous substances, namely polysaccharide gels, that protect mucosal surfaces by adhering to them. They may also act as prebiotics and influence intestinal flora.
• Marshmallow (Althea officinalis)
Used in humans for the management of inflammation of gastric mucosa.
• Slippery Elm (Ulmus fulva)
Used for inflammation and ulceration of the stomach and for cases of colitis.
• Licorice (Glycyrrhiza glabra)
Licorice has a similar effect, although slightly different mode of action, through increasing mucus production and promoting mucosal blood flow.
• Fenugreek (Trigonella foenum-graceum)
Used in the management of gastritis.

There are numerous herbs with antimicrobial effects. The mostly widely studied group for gastrointestinal infections are those containing the active component berberine. It has been found effective in treating diarrhoea caused by Escherichia coli, Shigella dysenteriae and Salmonella paratyphi B, amongst others. Berberine is found in plants such as goldenseal, Oregon grape root and coptis root.
Chamomile and thyme are also in this category although not of the berberine group. Chamomile oil is reported as having antifungal activity and activity against gram positive bacteria. Thyme oil has antifungal activities against a wide range of organisms.
Whilst there are several herbs considered as having antiviral properties, such as Echinacea, there is little information specifically for efficacy against gastrointestinal viruses. The exception being for tormentil root, which has been investigated for its effects against rotavirus diarrhoea in children. Research has shown an extract of tormentil root was effective in shortening the duration of rotaviral diarrhoea.
There is a considerable amount of research and evidence around the efficacy of some herbs, along with increasing understanding of their modes of action. As if often the case, equine specific research is limited and research from other species must be relied on.
Herbs that are well researched, are worth considering alongside a well-balanced approach to nutrition. The main challenge is not finding evidence of efficacy, but finding a source that is most appropriate to racing. Although herbs and extracts are readily available online, it is important to purchase through companies that are aware of the risks of naturally occurring prohibited substances and are managing this risk with a focus on racing, and not to use any supplement containing known banned substances.
References:
1. Kim DC, Kim SH, Choi BH, Baek NI, Kim D, Kim MJ, Kim KT. Curcuma longa extract protects against gastric ulcers by blocking H2 histamine receptors. Biol Pharm Bull. 2005, Volume 28, Issue 12
2. Mohamed-Amine Jabri, Nadhem Aissani, Haifa Tounsi, Mohsen Sakly, Lamjed Marzouki, Hichem Sebai. Protective effect of chamomile (Matricaria recutita L.) decoction extract against alcohol-induced injury in rat gastric mucosa. Pathophysiology, 2017, Volume 24, Issue 1
3. R Suja Pandian, C.V Anuradha, P Viswanathan, Gastroprotective effect of fenugreek seeds (Trigonella foenum graecum) on experimental gastric ulcer in rats, Journal of Ethnopharmacology, 2002, Volume 81, Issue 3
4. Masoud Ahmadnejad, Ghader Jalilzadeh-Amin, Benjamin W Sykes. Prophylactic effects of Glycyrrhiza glabra root extract on phenylbutazoneinduced Equine Glandular Gastric Disease (EGGD). Journal of Equine Veterinary Science, 2022, V olume118.
5. Stucchi, L. Enrica, Z. Alessia, S. Giovanni, S. Serena, C. Contura, B. Ferro, E. Ferrucci, F. Efficacy of the administration of a natural feed supplement in the management of equine gastric ulcer syndrome in 7 sport horses: a field trial. American Journal of Animal and Veterinary Sciences. 2017, Volume 12, Issue 3
6. M.T. Khayyal , M. Seif-El-Nasr , M.A. El-Ghazaly , S.N. Okpanyi , O. Kelber , D. Weiser. Mechanisms involved in the gastro-protective effect of STW5 (Iberogast) and its components against ulcers and rebound acidity. Phytomedicine. 2006, Volume 13, Issue 1
Recommended Reading
• Wynn, S.G & Fougere, B.J. Veterinary Herbal Medicine. 2007. Mosby Elsevier, Missouri.



Cavalor ArtiTec gives our equine athletes what they need during periods of intense work. Cavalor ArtiTec is the result of 7 years of scientific research (in collaboration with UGent) on optimum nutritional supplements for healthy tendons and joints in top-class sport horses. The resulting specific combination and balance of substances not only promotes healthy tendons and joints, it also offers ideal protection against damage caused by strain.
Backed by science, proven results.
Cavalor Arti Repair supports the natural healing process of joints and ligaments. For injured horses to speed up the recovery phase after overload.
race.cavalor.com
cavalor.com/race

IS SDF TENDINOPATHY A “PROFESSIONAL CONDITION” IN THE JUMPING RACEHORSE?
Tendon and ligament disorders are one major cause of poor performance and wastage in equine athletes. The most common structures involved are the superficial digital flexor tendon (SDFT), the suspensory ligament (SL), the deep digital flexor tendon (DDFT) and the accessory ligament of the deep digital flexor tendon (ALDDFT), also called the inferior check ligament.
Thoroughbred racehorses are particularly predisposed to tendon and ligament injuries accounting for approximately 50% of all musculoskeletal injuries to competing racehorses. However, some structures are much more exposed to injuries than others in this population of equine athletes.
Most tendon injuries in racehorses occur to the forelimb tendons, with overstrain injury of the SDFT at the very top of the list. This is particularly true in jump racing, where the prevalence of superficial digital flexor tendinopathy has been found to involve up to 24% of horses in training over 2 seasons (Avella et al. 2009) and could be considered as a “professional condition”.
The higher exposure of tendon injury in jumping horses compared to flat racehorses might be explained by the fact they compete over longer distances, for more seasons and are generally older than horses that race on the flat. Another reason is very likely that the SDFT of jumping horses support bigger strains, and repetitively, when landing over fences.
The main issue for this type of injury is that tendon healing is slow and requires a long recovery between 10 to 18 months depending on the severity of cases. Although the scar tissue of tendon injuries can be optimised with an effective rehabilitation program, its functionality remains inferior with relatively high re-injury rates in the years following the original lesion. Thus, a complete understanding of SDF tendinopathy and its major risk factors in jump racing are very important to improve prevention and early management of the condition which is potentially career ending. In the racing community, it has become crucial given the big issues it involves in sporting and economic terms, as well as for the health and the welfare of racehorses.
SDF tendinopathy is one of the most common injuries in jump horses with a prevalence from 10 to 45% depending on epidemiological studies with some variations among trainers. Most of the cases involve the forelimbs, but hindlimb injuries also occur. Typically, lesions are found at the mid-cannon level in a central core lesion.
The disruption of the tendon fibres might generally occur in this area because it appears to be preferentially loaded and degenerates more over the time. However, injuries of the
SDFT can be seen at all the levels of the tendon. They are most commonly unilateral, but bilateral SDFT injuries can also occur.
Tendinopathy is a result of mechanical overload, varying from single fibril disruption to complete rupture of the whole tendon. The most common cause of SDFT overstrain injuries in jump horses is an accumulation of damages from repetitive overloading.
The structure of the tendons in horses is matured around 2 years old, and after maturity there is very limited or no adaptation possible. It means that if tendons accumulate an excess of micro-damage over the time (tendon cells have a capacity to repair defects, but it is limited and need time), they become weaker with a loss of elasticity and strength leading to a point where higher SDFT loads / strains result in disruption of fibres with a clinical tendon injury.
Moreover, it is important to be precise that forelimb flexor tendons in racehorses function close to their maximal load / strain-bearing capacity with a narrow safety margin. While failure of the SDFT has been shown occurring for tensile strain (% increase in length from original length / tensile strain) from 12 to 20% in vitro, peak strains within SDFT at the gallop are by around 16%. Since racehorses operate close to the functional limit of the SDFT during fast work, any risk factors that lead to higher loads on tendons during training or racing can result in clinical injury with significant disruption of tendon fibres. Some of these in jump horses are discussed in this article.


Epidemiological studies have identified risk factors for SDF tendinopathy in racehorses. As discussed previously, jump horses are at greater risk than flat racehorses and it could be partially explained by horses being older in jump racing.
Indeed, risk of SDFT injuries increase considerably with age and it appears that the prevalence in jump horses is more important in horses older than 5 years old, with the maximum injury rate seen in horses 12 to 14 years of age.
Other major risk factors identified for SDF tendinopathy are frequent high-speed work, longer race distance, harder racetrack surface, heavier bodyweight and longer training career. Although they were not clearly identified as such, fatigue in relation with exercise duration or lack of fitness and conformation / shoeing (long toe, low heel) might increase the risk of SDF tendon injuries.
In jump racing, SDF tendonitis appeared more common in steeplechasers than in hurdlers, but the reason may be the older age of the first ones rather than the type of racing.
Assessment of suspected tendon injuries should be based on history and clinical signs associated with diagnostic imaging. In many racing stables, people assess forelimb flexor tendons daily which can help to detect the early lesions of SDF tendinopathy. However, first signs may be very subtle and variable depending on history, severity and location of injury. They are usually noted within 24 hours of fast work or racing but can also develop at slower work. It is often subclinical and resolves quickly for non-severe injuries with acute lesions characterised by heat, soft tissue swelling and pain on palpation, whilst chronic ones appear with fibrosed thickening.

Superficial digital flexor tendon
Proximal suspensory ligament
Deep digital flexor tendon
Extensor branch of suspensory ligament
Suspensory ligament
Superficial distal sesamoidean ligament
Deep digital flexor tendon


The prevalence of superficial digital flexor tendinopathy has been found to involve up to 24% of horses in training over 2 seasons.


Overstrain SDFT injuries are classically in the mid-cannon area and present a more or less severe change in profile of the back of the limb leading to the well-known qualification of “bowed tendon”.
However, the obvious signs of inflammation (thickening and heat) are not always present even for some significant injuries and lameness doesn’t appear to be a very consistent feature associated with SDFT injuries. It is typically mild (1 to 2 grades out of 5 at the trot) and improves rapidly over the first week after the injury, however the tendon remains weakened. Consequently, the level of lameness and pain on palpation don’t have a good correlation with the severity of the lesion, except in the most severe cases.
In cases of apparent “bowed” injury with pain response on palpation, it is sufficient to consider there is likely an active tendonitis. In more subtle configuration, the need for ultrasound is indicated to confirm and assess the extent of the lesion.
It may be best to perform or repeat tendon scans at 1 to 3 weeks after clinical injury is first noted. Indeed, it allows us to assess lesion severity more accurately because of ultrasonographic underestimation of lesion extent at the beginning of tendon injuries. It is also very important in cases of suspected lesions but initially not well defined.
Moreover, both tendons should be systematically examined on ultrasound for 2 major reasons. Firstly, SDF tendinopathy are bilateral in up to 67% of cases (Webbon), and secondly it helps to differentiate active lesions versus subclinical changes on ultrasound (ex. “juvenile tendinitis”). A careful ultrasound assessment is also keen to exclude the presence of potential concomitant lesions (ex. SL desmitis).
When SDFT lesions are suspected, the horse should be put at stall rest with only short hand walking until the injury is confirmed or not by ultrasound a few weeks later.
Ultrasound is routinely used by equine veterinarians and is elected to diagnose SDFT injuries as first-line diagnostic imaging. Whilst it is particularly relevant to document tendon lesions, it has been beneficial to develop a scoring system using specific measurements in order to categorise the severity of SDF tendinopathy.
It is also very useful to establish prognosis and monitor the healing process in line with an adapted rehabilitation program.
The prognosis of SDF tendinopathy can be very variable depending on the severity of injury, the convalescence program and the type of racing. Overall, sport prognosis in the thoroughbred is guarded with a reported return to racing from 20 to 60% of cases. The major issue of tendon injuries in racehorses is the need for a long recovery and the high rate of reinjury due to poor regenerative capacity of tendon tissue, which is considered as a limiting factor for racing. However, return to training / racing activity is common for most mild / moderate SDFT injuries.
A study with jump racehorses affected by SDFT injuries classifying lesions severity by ultrasound established that all horses with mild lesions returned to training, and 63% raced. 50% of moderately affected horses returned to training, and 23% raced.
In severe lesions, only 30% of horses resumed training, and 23% raced. In the study, the mean of reinjury rate for horses resuming work was 40% over a period of follow-up from 9 to 30 months, but some studies with longer follow-up reported up to 80% of horses sustaining a re-injury. Also, it is remarkable to note that a significant number of re-injuries affect the opposite normal limb.


Definitely, long-term prognosis is influenced by the severity of the lesions. The more severe SDFT lesions are, the lower chance of return to racing, shorter racing career and drop in racing class of those resuming there are. Complete ruptures of SDFT are hopeless for sport prognosis, but paddock life remains possible.
The other factors established to influence the sport prognosis in racehorses affected by SDFT lesions are concomitant lesions, and more particularly bilateral tendinitis which have very poor prognosis. The less classical SDFT lesions like those at the level of carpal or proximal cannon have poorer prognosis for racing and ongoing lameness is frequently present.
While it is difficult to study the influence of rehabilitation programs due to the need for a long period of follow-up, controlled exercise showed to provide better prognosis than only uncontrolled pasture rest.
Treatment & Management:
How to optimise the healing of tendon lesions?
Contrary to bone, healing of tendon lesions doesn’t allow you to get back pre-injury tissue due to its poor regenerative capacity. It means the structure and function of healed tendons are modified with different mechanical properties. Thus, the aim of SDF tendinopathies’ treatment is to optimise the healing process in order to get a strong and functional repaired tendon as much as possible.
Although there are different options available in the management of SDFT lesions in racehorses, all of them should respect a long recovery with progressive return to work. As said previously, tendon healing is slow, and it is common to consider at least 12 months for return to racing in horses affected by SDFT injuries.
To understand how to manage SDF tendinopathy, it is important to consider the different phases in the tendon healing process.
In the initial days following the injury, the acute phase, is characterised by inflammatory reaction. For a long time, it was advised to control quickly and aggressively the inflammatory response to limit damage to the tendon. However, it is now more and more controversial because the initial inflammatory phase would be beneficial for the repair process of tendons.
The best management of this phase is to treat only in case of excessive pain and acute swelling through the use of antiinflammatory drugs and cold therapy locally for a period of 3 to 5 days. During this phase, it is important to minimise exercise with stable confinement for the initial weeks. As we discussed previously, the ultrasound assessment of tendon injuries is generally best performed 1 to 3 weeks after the initiation of the injury because it allows to determine the full extent of the lesion. Thus, it is recommended to scan flexor tendons at the end of the acute phase to grade the severity of the lesion and establish a rehabilitation program and prognosis for return to racing activity.
The other crucial period in the management of SDF tendinopathy is the rehabilitation phase which can begin soon after the inflammation subsides. The cornerstones of healing tendon are the need for time and progressive graded and controlled exercise program. Protocols are quite empirical due to the difficulty to compare long-term outcome with homogenous groups.
Indeed, the program should be determined in relation to the severity of the injury, but classically at least 6 months are necessary for return to cantering. A typical program is to introduce walking once the acute phase has passed with gradual
increasing duration until 12 weeks. Ideally, monitoring of healing with ultrasound assessment every 3 months allows to control the evolution of the repair through an assessment of fibre pattern alignment and tendon/lesion size. In normal evolution, trotting can be introduced after 12 weeks and cantering after 32 weeks. Generally, the re-introduction to normal race training is resumed before 8 to 12 months. Prognosis of SDFT lesions reported for horses rested for less than 6 months is poorer with higher risk of re-injury.
Additional therapies can be used in the aim of optimising the healing of tendon tissue after injuries. Some of them are more and more popular and promising, but it is still difficult to evaluate and compare their efficacy. These modalities have to be considered as an additional intervention to graded exercise programs.
The main interest of these therapies is not to reduce rehabilitation, but to optimise the healing process reducing the chance of re-injury after return to training. These additional therapies range from firing to intralesional therapies with PRP (Platele-rich plasma), PSGAGs (Polysulfated glycoaminoglycans), growth factors (IGF-1) or stem cells. To optimise the efficiency of these therapies, the treatment should be generally realised during the acute phase (more or less 2 weeks after the initiation of the injury).































































































































































































































































































































Incorporating treadmill use in training programmes helps minimise the horse accruing excessive body condition and ensures maintenance of good dorsopalmar foot balance.
Prevention is very important due to long recovery and guarded prognosis linked to high re-injury rate. 23–67% of horses with tendon injury treated using conservative methods will re-injure their tendons within 2 years of the original injury.
Strategies with success in preventing/reducing the incidence of tendon injury have not been validated; however, awareness of risk factors associated with SDF tendinitis provides some useful guidance.
• Avoid excessive training to fatigue and permit sufficient recovery time after racing or high-speed training.
• Avoid use of poorly prepared or inappropriate track surfaces.
• Long-term use of exercise boots/bandages may also contribute to increased risk; magnitude of this risk is unknown but should be balanced against rationale for routine use of bandages in horses that are not prone to interference injuries.
• Strategies to reduce risk of reinjury of a rehabilitating/ rehabilitated tendon have also not been validated; however, it is rational to limit excessive loading of tendon.
• Possible aspects to assist with above: incorporate treadmill use in training programme; attention to rider weight; minimise horse accruing excessive body condition; ensure maintenance of good dorsopalmar foot balance.
• Possible benefit to be derived from regular post-exercise cryotherapy (such as cold water immersion): cooling the lower limb effectively can reduce enzymatic activity in tendon and potentially inhibit cell attrition resulting from highintensity exercise.

Tracks that are very hard result in higher speeds and increased peak impact loads. These fast tracks are therefore more likely to produce overstrain injuries of tendons.
However, tracks where the surface is uneven, slippery, or shifty seem also to contribute to damaging loading patterns on tendons. Numerous factors influence the mechanical behaviour of a track surface; the weather and track maintenance have a major influence. Moisture content affects all tracks’ mechanical properties, and extreme temperatures appear to affect some synthetic tracks’ mechanical characteristics dramatically.
Experience over years with a particular track type will allow identification of track conditions that may predispose to tendon injuries.
Fatigue is influenced primarily by the horse’s work schedule, level of fitness, and intensity of competition. Fatigue should be considered as a contributor to tendon injuries. With the onset of muscle fatigue, a horse’s stride characteristics change, altering the forces on the tendons. Fatigue in any sport results in an inevitable loss of form and coordination in each stride, which is likely to result in an increased risk of injury.
At high speed, lameness may result in excessive loading of the tendons in the contralateral limb.
Horses who are overweight or carrying excess weight will produce greater forces on their tendons compared with lower weight individuals.
In conclusion, tendon and ligament disorders prove to be a major cause of poor performance and lameness within the racing industry. With SDF tendinopathy being at the forefront of these lameness’, there are many strategies that can be adopted to prevent / reduce the incidences of tendon injuries within the thoroughbred.









The link between a healthy gut and overall health in both humans and equines has long been promoted by scientists and veterinarians.
Now a new study by the University of Surrey provides the clearest link yet between gut health and athletic performance in thoroughbred racehorses, it identifies a “critical window” for immunological development which may provide owners and trainers with a glimpse into a racehorse’s future success on the track.
The study, published in the journal Scientific Reports, found that the composition of gut bacteria at just one month old can predict future athletic performance – measured by BHA official ratings (OR), earnings and placings – with a greater diversity of gut bacteria associated with better performance metrics. The study also found that foals with lower bacterial diversity at just 28 days old had a significantly higher risk of respiratory diseases and even soft tissue injuries later in life.
The study’s lead, Professor Chris Proudman, has dedicated his career to equine gastrointestinal health; first as a veterinary surgeon specialising in the clinical management of colic cases and latterly as head of the University of Surrey’s School of Veterinary Medicine. Since stepping down as Head of School last year, he now devotes his time to horse gut research. “I’ve got a small group of people investigating various aspects of intestinal health in horses, particularly around bacterial populations associated with health and disease,” he tells Trainer Magazine. The latest study is the culmination of more than a decade’s worth of research into the influence of gut bacteria on the development of immunological competence and susceptibility to disease. “I was aware of emerging evidence in the human field to suggest that these early life gut bacteria are really important in priming the immunological system and effectively setting up humans or animals for a healthy life in the future,” he says. “So with funding from ALBORADA Trust [the study’s sponsor], this was an opportunity to look in more detail at the impact of early life experiences in foals.”
So how does gut bacterial community structure in the first few months of life predict the risk of specific diseases and athletic performance in racehorses?
To answer that question, Professor Proudman and his team performed DNA sequencing on faecal samples from 52 thoroughbred foals born across five stud farms in 2018. These samples were collected at nine sample points within the first year of the foals’ lives: at 2, 8, 14, 28, 60, 90, 180, 272 and 365 days old. In addition, weekly written or verbal health updates were obtained for all horses reporting any veterinary investigation or treatment for orthopaedic, soft tissue, respiratory or gastrointestinal disease or injury. The researchers then compared this with the horses’ athletic performances at 2 and 3 years old: finishing position and OR were obtained after every race start, while total prize money earnings and cumulative performance metrics (total starts, total placings, total wins) were collected for all race starts until the end of December 2021.
The findings were striking. Not only did researchers observe that the athletic performance of the foals was positively associated with higher faecal bacterial diversity at just one month old, they also identified that a higher abundance of the bacteria Anaeroplasmataceae was associated with a higher OR, and increased levels of the bacteria Bacillaceae at 28 days old were linked to higher race placings. “We weren’t necessarily expecting to see [a correlation between gut health and performance], so the fact that early life gut bacteria influenced athletic performance came as a bit of a surprise to us,” admits Professor Proudman. “But it is consistent with the whole picture around health,” he continues.

Professor Proudman is hesitant to attribute too much importance to the precise identity of the bacteria that were present: “I think what is probably more important is what those bacteria are doing, the mechanism by which those bacteria are affecting the animal, and we don’t understand that at the moment,” he suggests. The two different bacteria identified “could potentially be doing the same thing or they could be doing different things,” he continues. “It’s just an indication that there are bacteria that have a beneficial effect.” Further study is planned to try to identify in more granular detail the precise bacteria that are important to a horse’s performance. Nevertheless, the findings are the best evidence to date of a causal link between gut health and athletic aptitude: “This is really hard science that there are measurable beneficial effects both in terms of health and in terms of performance associated with diversity of the gut bacteria, and also with species of bacteria if they are present at this very early stage in life,” says Professor Proudman.
The concept of a “critical window” for immunological development is not new. Many lines of evidence point to the existence of such a period, during which time the immune system can be “trained” to tolerate particular microbes, and thus avoid later destructive immunopathology associated with these same microbes. While the window has been demonstrated in laboratory animals, “humans studies haven’t really been able to nail down the time period,” says Professor Proudman. “Most of the human studies state that it’s somewhere between birth and weaning,” he continues. “That’s a window of about 6-8 months for a lot of human babies. Because we were able to sample our foals very frequently during the first six months of life, we’ve been able to identify with a reasonable degree of accuracy a critical window for performance that happens very, very early – the first 28 days,” says Professor Proudman. Again, Professor Proudman is cautious about drawing a hard line at the 28-day mark: “I wouldn’t obsess about 28 days exactly – I think this is just telling us there’s something really early in life, in the first few weeks, which is the critical period,” he says.



Studies show that a higher abundance of certain bacteria at 28 days old can be associated with a higher OR and linked to higher race placings.

It is not only future athletic performance which is determined within this critical window; higher bacterial diversity at 28 days old was significantly associated with a reduced risk of respiratory diseases later in life. “It’s likely that what we’re looking at here is the process of immunological priming,” explains Professor Proudman. Immunological priming is the process by which a host improves its immune defences following an initial pathogenic exposure, leading to better protection after a subsequent infection with the same – or different – pathogens. Or to put it another way: “When the horse (or any animal) is first born, the body has to learn to recognise the difference between the ‘self’ and the ‘non-self’ –the potential organisms, bacteria and viruses that are trying to invade the animal. And then it learns to fight those off,” explains Professor Proudman. “But there’s an initial learning period – this so-called period of immunological priming – and it seems that bacterial composition of the gut is important because the gut is a really important interface between the animal and the external environment,” he continues. “And that’s where this immunological priming takes place.
“This is the area in which most of the human research has been done, particularly around respiratory disease. And there’s really good evidence in both human and animal models that the gut microbiota have a significant impact on the development of the early immune system very early in life. So it’s highly likely, although we didn’t look at it specifically in our study, that this is an immunological effect that we’re seeing.”
The Flexineb® E3 is a portable, silent equine nebuliser. Battery or mains-operated, it can be used for daily airway maintenance therapy prior to racing and the targeted delivery of inhaled medication for the management of equine airway disease.
Nebulisation of non-prohibited substances complies with FEI General Regulations.


Researchers also identified a positive association between the abundance of the particular bacteria Streptococcaceae and Moraxellaceae and the risk of soft-tissue health events such as infected wounds, cellulitis and abscesses. “There are specific bacteria that we know cause soft tissue infections,” explains Professor Proudman. “And again, it’s that resistance to bacterial infection that is mediated by the immune system.”
But where do these bacteria come from, and what could the answer mean for the way racehorses are bred and reared? The answer appears to be partly nature and partly nurture. Your gut is full of trillions of bacteria and other microbes help you digest food and support immune, heart and brain health. These are known collectively as the microbiome. It has long been thought that foals (and humans) are first exposed to microbes when they pass through their mother’s birth canal. However, evidence from human studies suggests that babies may come into contact with some microbes while inside the womb. A follow-on study by Professor Proudman’s team, scheduled to commence in early 2025, aims to identify where exactly the bacteria come from by tracking pairs of mares and their foals. But for now, “it’s a question that we don’t currently have an answer to,” concedes Professor Proudman. “People have had theories and you can make plausible explanations of where they might come from. Extrapolating from humans, the suggestion is that a lot of those bacteria actually come from faecal contamination of the foal by the mother. But there’s some really intriguing evidence around breast milk, for example.”
Certainly, the gut microbiome continues to diversify as the foal matures, suggesting environmental factors play a role. This includes the food they eat as well as factors such as whether antibiotics are administered. Ah, antibiotics. The epidemiological elephant in the room. Any discussion around antibiotics inevitably leads back to antibiotic resistance. Also known as antimicrobial resistance (AMR), antibiotic resistance is when bacteria change so antibiotic medicines can’t kill them or stop their growth. This makes certain bacterial infections

difficult to treat. AMR is caused by the misuse and overuse of antimicrobials in humans, animals and plants. The World Health Organisation has identified AMR as one of the top global public health and development threats. (It is estimated that bacterial AMR was directly responsible for 1.27 million global deaths in 2019 and contributed to 4.95 million deaths.) So what does this have to do with racehorses? Professor Proudman’s team also investigated the long-term impact of foals receiving antibiotics during the first month of life. It was found that these foals had significantly lower faecal bacterial diversity at 28 days old compared to other foals who did not receive such treatments. Further analysis revealed that these foals won significantly lower prize money earnings (an indicator of athletic performance) in their subsequent racing careers. In addition, foals who received antibiotics during their first 28 days of life had a significantly increased rate of developing a respiratory disease compared to their counterparts.

“Clean Getaway has been thriving since coming back into work and has continued to improve with each run. His recent quartet of wins, adding to his impressive tally of 6 wins in 6 months, goes to prove the ability of TopSpec feeds helps to maintain him at his peak fitness for a sustained period, and he looks tremendous with it too.” Phil Kirby






While the study does not necessarily demonstrate causality, “we can demonstrate an association between an event, in this case the composition of the microbial community in the gut and a downstream outcome which is either a health related event, or performance,” explains Professor Proudman. “We go to pains in the paper to say we can’t prove that it’s causal,” he emphasises. “However, as we say in the paper, we do believe that a causal association is a credible interpretation of our data. And one of the strongest reasons for this is simply the timeline. We’ve got something happening early in the animal’s life that is then leading to something that happens much later on in the animal’s life. A plausible explanation is that the antibiotics are hitting the gut bacterial population, disrupting it, and then that, in turn, is disrupting immunological development, which leads to an animal that is more susceptible to respiratory disease.”
While it is recognised that antibiotics play a vital role in treating infections and protecting the long-term health of foals, Professor Proudman is clear that they need to be used responsibly: “[AMR] can develop in animals and then transfer to humans and vice versa. So it helps everybody to minimise the use of antibiotics. Even accepting that some foals need to have antibiotics for medical reasons, if there’s something we can do to minimise the damage that those antibiotics do to gut bacteria, that’s the question we’re asking.”
So what are the implications of this research for the racing and breeding industries? “I suspect the gut microbiome is only part of the story,” says Professor Proudman. “There are lots of other factors [that contribute to a horse’s health and performance], such as genetics, environment, and its response to training. I don’t think we are anywhere near a situation yet where we’ll be able to screen horses for potential on the basis of their bacterial communities,” he says. “However, I think there are some really simple things that the racing industry and, in particular, the breeding industry could take on board which could help them.”
To that end, a follow-on study, funded by the Horserace Betting Levy Board, will look for potential probiotic bacteria
Gut bacteria can impact foals’ health and ultimately their performance.

that can be fed to foals in the form of feed supplements that will then colonise their intestine and produce beneficial effects.
“In the same way that you could go to the supermarket and get yoghurt with probiotic bacteria in them, we’re identifying bacteria which might do the same thing for horses; in particular, for foals,” explains Professor Proudman. His team is already working with various players in the feed and supplement industries. “There might be some new products in development within the next few years directly arising from this research,” he hints.
“The thoroughbred breeding industry is very traditional,” Professor Proudman continues. “And I think there probably has been an under-recognition of the genetic contribution of gut bacteria to foals’ health and ultimately their performance. It’s quite theoretical at the moment and we need to explore it in more detail. But certainly I think in the future, if stud farms have mares that have good, healthy gut bacteria, we think that’s going to be passed on to foals. So, it’s another aspect of racehorse genetics that has value as a commercial proposition.”




Through the professionalism and expertise of our staff, together with the fantastic range of facilities, our goal for both rehabilitation and pretraining is to return every horse to its owner/trainer with the optimum chance of fulfilling its potential.
LCER operate from a tranquil environment, based in Suffolk. We have the ability to work with the latest technology coupled with the wonderful facility that has been developed at Leys.
Louise Collinson mobile +44 (0)7792 260666 email lou@lcequinerehab.co.uk
address Leys Farm, Church Lane, Barnardiston CB97TL
www.lcequinerehab.co.uk

DID YOU KNOW?
A horse cannot consistently perform to the best of its ability with a gut flora imbalance. ProSol is a unique probiotic solution tailored to each horse, containing live beneficial bacteria harvested from the horse’s own faecal sample, which helps to restore gut flora PLUS the IEC has a bacterial cryopreservation service to preserve these bacteria for the horse’s lifetime –providing a safety net for your horses’ lifetime.

Using ProSol ensures your horses gut flora is healthy thereby helping to increase immunity, prevent disease & ensure consistent performance.

I have been using the ProSol probiotic service for some time and I appreciate its innovative concept and the fact that it’s a natural product.
It has become an important tool for training my racehorses and maintaining their wellbeing.
ProSol contains only the horse’s own beneficial bacteria suspended in sterile water.
Contact the Irish Equine Centre to talk to our experienced microbiologists who will formulate the probiotic unique to your horse.
IRISH EQUINE CENTRE, Johnstown, Naas, County Kildare, Ireland +353 (0)45 866 266 • microlab@irishequinecentre.ie • www.irishequinecentre.ie



If entering the winter, your breeding prospects have come up empty, there are considerations to ponder and actions you can take for successful breeding next year. “Don’t let those mares sit all winter, with untreated conditions such as a uterine infection,” says Dr. Tracey Chenier, Theriogenologist and researcher from the Ontario Veterinary College at the University of Guelph. “Have a thorough veterinary evaluation now to help ensure her uterus is clean and she is healthy and cycling early next year, for the best chance of a positive outcome.”

SCAN QR CODE TO VIEW DR. CHENIER’S SUCCESSFUL BREEDING TIPS
“The number one reason your mare didn’t get pregnant in any given year may be due to uterine infection,” says Chenier. “The term we use is endometritis.” Most often caused by a bacterial infection, it is often associated with poor perineal conformation. In other words, your mare has a tilt to her vulva causing the vagina and uterus to become contaminated with bacteria every time she defecates. It is also common for these mares to wind suck, which can lead to infection and inflammation that results in a hostile environment the embryo cannot survive in. A minor surgical procedure known as a Caslick’s suture reduces the chance of contamination in most affected mares. Severely affected mares may require additional procedures to reconstruct the perineal body. Another common form of endometritis is PBIE, or persistent breeding induced endometritis. In these cases, there is a prolonged inflammatory response to semen and contamination that occurs at breeding. Again, the mare has a hostile uterine environment in which the embryo cannot survive. To improve the chance of conception, this condition can be managed by ultrasound within 6 to 12 hours after breeding. She is checked for fluid retention and inflammation and if present, the uterus is lavaged to remove the fluid and calm the inflammation. The veterinarian may also advise administration of oxytocin to increase uterine contractions and help remove the fluid.

Cultures, gained from swabs of the uterus, are performed to detect inflammation and infection.
Another very common reason for the mare not getting pregnant is their age. “We actually consider mare’s fertility to decline as early as 12 years of age,” says Chenier, “and that surprises people that as early as 12 years, their fertility can decline significantly.” Older mares can have poorer oocyte (egg) quality. This reduces their chances of getting pregnant and can result in higher rates of mid-gestational losses.
Older mares are more susceptible to many circumstances including uterine conditions, metabolic disease, changes to the uterus, fibrosis and cysts. Fibrosis of the uterus will reduce the chances of carrying a pregnancy to term. Endometrial cysts or fluid filled sacs in the lymphatics of the uterus can block the ability of the embryo to move around and interfere with the placenta formation.
“Stress, nutritional issues, and hormone deficiencies can make it difficult for an embryo to survive,” explains Chenier “but these issues are generally less common.”
The corpus luteum is the structure that forms on the ovary after the mare ovulates and its progesterone production maintains the pregnancy early on. This structure may be susceptible to effects of severe stress, illness, or inflammation in the uterus. Progesterone/altrenogest supplementation can often save these early pregnancies but the mare will have to stay on the supplements until the fetoplacental unit takes over pregnancy maintenance by 120 days. The fetoplacental unit is a crucial interface between maternal and foetal circulatory systems, providing essential nutrients and oxygen to support foetal growth and development.

Early pregnancy loss can happen from days 0–60 of gestation. To help avoid risk factors like excessive stress, ask your vet before changing or adding anything to your mare’s routine. Consult your vet before administering any vaccines or deworming products.
“Oviductal blockage is another uncommon condition,” says Chenier, “but in mares that are not conceiving and everything else is normal (no uterine infection, good stallion fertility…) it should be considered.” An effective treatment the veterinarian may suggest, involves applying the hormone prostaglandin E to the oviductal papillae, which opens the oviduct and allows that blockage to be cleared out.
“A good reproductive evaluation is really important to find out the reasons why a mare either didn’t get pregnant or lost a pregnancy,” says Chenier.
Veterinarians use rectal palpation, especially with ultrasound, to help detect fluid and infection. Palpation with ultrasound can detect the presence of endometrial cysts, conditions on the ovary, such as failure to ovulate and ovulatory follicles.
Cultures, gained from swabs of the uterus, are performed to detect inflammation and infection. This is helpful in cases where antibiotic use is required in order to determine what type of antibiotic to use.

Uterine biopsy is indicated in certain cases. “I recommend a biopsy in any mare that fails to get pregnant after three attempts, especially if we are not getting good answers on a swab culture and ultrasound,” says Chenier. As well as providing a prognosis, it provides a lot of information on treatment options to improve the mare’s fertility.
A biopsy can help provide better information about what’s going on in the uterus and in the case of inflammation, identify the type of inflammation present.
Chronic infections are more likely to be caused by something like a dormant strep infection, and biopsy may be the only way to diagnose the fibrosis of the uterus that would be directly related to prognosis. If you found out your mare’s uterine biopsy was a Grade 3, meaning she has a lot of permanent severe changes in that uterus, her likelihood of carrying a foal to term is between zero and ten percent. This is really important information to help the breeder to decide whether they want to invest the time and money to attempt to breed a mare with a prognosis revealing these challenges.
Ultrasound is useful in identifying conditions such as endometrial cysts. Cysts can be removed by putting an endoscope in the uterus and then using either laser or electrocautery to a blade to improve a mare’s chances of pregnancy. Electrocautery involves using a heated electrode to cut or coagulate tissue during surgery. When applied to a blade, it allows for precise cutting with minimal bleeding.
“In really rare cases where all else has been ruled out, a karyotype might be considered,” says Chenier. “If it’s a young maiden and everything else seems to be working, there may be a genetic reason that she’s not able to get pregnant, but that would be the exception.”
Karyotyping involves staining chromosomes and examining them to identify structural changes or numerical abnormalities.
Oxytocin can be administered to increase uterine contractions and help remove the fluid.




The all-important veterinary evaluation will check the mare’s general health, body condition and uterine health as well as rule out metabolic diseases like insulin resistance and Cushings.
One must ensure the broodmare’s nutritional needs are met. Calories, protein, vitamins, and minerals are all passed on to the foal while in utero. Consult your vet or an equine nutritionist to ensure your mare gets a balanced diet and to learn how her nutritional needs increase during pregnancy.
Use of light to manipulate the season is a consideration if you want to breed your mare early in the season for a January –March foal. Mares stop cycling during the winter. “I think it’s helpful to expose the mare to the cold and the darkness of the fall to reset her system before you start her under lights,” say’s Chenier. She recommends lighting programs begin around December 1st with what amounts to ten-foot candles, which is equivalent to 100 lux intensity of light. In old style lighting with incandescent bulbs that was the 100 watt bulb and the old saying was you needed to be able to read a newspaper in every corner of the stall. 16 hours of total light per day is recommended, and this includes natural light. From a practical point of view, that means if you turn your mare out at 8:00 o’clock in the morning, bring her in at four, and have the lights on in the stall until 11:00 PM, you will be providing an adequate amount of light. Chenier also describes the use of a commercially available equine light mask that is worn 24/7, like a fly mask. It is battery powered and delivers blue light to one eye on a timed basis.



“Good breeding management is always key,” emphasises Chenier. “Negative uterine swabs before breeding ensure the mare is free of infection, limit to one cover in mares prone to infection or inflammation, correcting poor perineal conformation and then practise optimal timing.”
Not breeding at the right time is much less likely in the thoroughbred industry, where mares are being bred by natural cover. If the mare is not in heat and not ready to ovulate, she is not likely to stand for the stallion.
If a mare is bred too early, the sperm will not live long enough. Mares can stay in heat a day or two after they have ovulated. If breeding happens too late (after ovulation), the oocytes will no longer be viable.
If the chosen stallion has fertility issues, the breeder may need to closely monitor their mare’s ovulation for the most optimal timing of breeding to improve odds of success. Chenier says, “If their sperm doesn’t live very long inside the mare, we have to manage those cases differently and make sure we’re breeding those mares really close to ovulation to get good fertility for those stallions.” Stallion fertility should always be considered a possibility when mares are not conceiving.
If breeding early in the season, one needs to make sure the mare is cycling properly and not just in spring transition. A vet check will confirm the mare is experiencing a real heat and ovulating for early breeding (Feb – April).
Equine Guelph’s Mare & Foal Healthcare tool provides many resources such as free broodmare and foal nutrition information sheets, handy checklists, and a pregnancy wheel to see how the foal develops in real time. It also offers a selection of videos featuring Dr. Chenier on predicting and monitoring foaling. Equine Guelph, at the University of Guelph, also offers a 12-week online course providing an understanding of effective broodmare, stallion and foal management and the procedure of producing quality foals while ensuring a sound understanding of welfare assessment and guidance for making good ethical decisions in relation to breeding. Register online at: courses.opened.uoguelph.ca







Every thunderous stride of a racehorse is a delicate balance between power and vulnerability, and the surface beneath their hooves can make all the difference. Whether it’s turf, dirt, or synthetic tracks, these surfaces aren’t just where races are run, they play a critical role in protecting the health and welfare of the horses. The composition, maintenance, and resilience of these surfaces directly impact the likelihood of injuries, affecting everything from joint strain to catastrophic breakdowns.

In an era where the welfare of horses is more scrutinised than ever, the choice and upkeep of racing surfaces have become critical. Turf requires precise irrigation and aeration to remain safe and consistent; dirt demands meticulous grading and moisture control to prevent compaction; and synthetic tracks, though engineered for uniformity, must be closely monitored for temperature sensitivity and degradation over time.
But the challenges don’t stop there. With climate change rewriting the rules of weather patterns, bringing heavier rains, harsher droughts, and rising temperatures, the very nature of these tracks is being put to the test. Maintaining consistent conditions under these shifting extremes will require innovation and a commitment to sustainability, as the racing industry navigates the intersection of performance, safety, and environmental responsibility.
Traditionally, turf tracks dominate the European horse racing scene, serving as the primary surface in most racecourses due to their ability to provide optimal conditions for racing, particularly during the milder months.
However, in recent years, there has been a growing interest in synthetic surfaces, across Europe, where these tracks are gaining traction for their ability to withstand the challenges posed by winter weather. Major racecourses across the continent utilise synthetic surfaces like Polytrack and Tapeta to ensure safe and consistent racing even under adverse weather conditions. Synthetic tracks are particularly valued for their superior drainage, stability in cases of frost and heavy rain, and different maintenance requirements compared to turf, offering a practical and modern solution to tackle climate challenges while maintaining a continuous racing calendar.
Dirt tracks are now almost entirely absent in Europe, with rare exceptions at a few minor racecourses where the quality of racing is generally low. This is because dirt surfaces neither provide the technical advantages of synthetics nor carry the prestige and tradition associated with turf. The shift toward synthetic surfaces, particularly noticeable in regions with harsher winters, is gradually establishing itself as a key trend for the future of European racing, while the dominance of turf remains unchallenged for the most prestigious events.
The ongoing shift in surface preferences reflects a broader focus on equine welfare, a priority that has spurred significant research and collaboration among leading organisations in the racing industry. The adoption of synthetic tracks, driven in part by studies highlighting their safety benefits, is a direct response to growing concerns about horse injuries and fatalities. A key driver behind this shift is the safety record of synthetic tracks compared to other surfaces.
Data from studies, such as those conducted by The US Jockey Club’s Equine Injury Database (EID), provide critical insights into this trend. According to
the EID, synthetic tracks report significantly lower rates of catastrophic injuries, approximately 1.2 incidents per 1,000 starts, compared to dirt tracks, which average 2.1 incidents per 1,000 starts, and slightly lower than turf tracks, which average 1.6 incidents per 1,000 starts. These findings underscore the uniformity and predictability of synthetic surfaces, which minimise variability in footing and reduce the risk of uneven impact during high-speed gallops. Additionally, synthetic tracks are less susceptible to environmental factors, such as extreme wet or dry conditions, which can compromise the performance and safety of both turf and dirt surfaces.
Several prominent organisations have dedicated substantial resources to studying the relationship between track surfaces and equine health. For instance, The US Jockey Club, through the EID, has compiled data since 2008 that consistently demonstrates the superior safety profile of synthetic surfaces, providing a foundation for their increasing adoption, particularly in regions with demanding climates or high year-round racing schedules.
Similarly, the British Horseracing Authority (BHA) conducts comprehensive reviews of racecourse safety, ensuring that maintenance protocols and track designs align with welfare goals.
In France, France Galop has implemented robust injury monitoring systems, using the insights to refine track conditions and better match surface types to their environmental contexts. These efforts underline the growing recognition that track surfaces play a pivotal role in reducing injury risks, particularly in the high-impact phases of a horse’s stride, as detailed in research such as the Equestrian Surfaces Guide. Despite the demonstrated safety advantages of synthetic surfaces, debates remain regarding their long-term impact on equine health. Critics suggest that synthetic tracks may contribute to soft tissue stress injuries due to their firmer composition compared to well-maintained turf.
Building on the findings of the Equestrian Surfaces Guide, it becomes evident that the biomechanical interaction between the horse and the track surface is a critical determinant of safety and performance. Each phase of the stride: landing, support, and rollover, introduces distinct biomechanical stresses that vary based on the surface’s composition, maintenance, and environmental conditions.
This research, further supported by Dr Mick Peterson’s, Racing Surfaces White Paper, highlights the importance of not only selecting appropriate surface types but also ensuring consistent maintenance to reduce injury risks.
Peterson’s study provides a detailed analysis of how surface properties, such as firmness, cushioning, and grip, directly influence the forces acting on a horse’s legs during high-speed galloping. The white paper emphasises that well-engineered synthetic tracks excel in delivering predictable and uniform performance, mitigating the variability often associated with dirt and turf surfaces.
For example, in the landing phase, when shockwaves and braking forces are transmitted through the leg, synthetic tracks are designed to provide a controlled level of slide, dissipating some of the impact forces and reducing stress on the hoof and distal limb. In contrast, surfaces with excessive grip, such as poorly maintained dirt, amplify these forces, increasing the risk of injuries.
During the support phase, when the hoof absorbs up to 2.5 times the horse’s body weight, surface uniformity becomes critical. Peterson’s research underscores that uneven surfaces, like waterlogged or overly compacted turf, can lead to uneven load distribution, raising the likelihood of strain injuries to tendons, ligaments, and joints.
Synthetic tracks, with their engineered shock-absorbing properties, excel in maintaining stability during this phase, effectively minimising these risks. The rollover phase, where propulsion forces peak, also places significant demands on grip and shear strength. Synthetic surfaces are particularly effective here, offering consistent traction to prevent slips while avoiding the overstress on tendons and ligaments caused by overly hard or high-grip surfaces.
In addition to biomechanical insights, Peterson’s white paper emphasises the importance of consistent surface maintenance. Even the best-engineered tracks can lose their safety advantages without proper upkeep. The study highlights the need for regular monitoring of moisture levels, compaction, and grip, alongside the use of advanced tools like surface testing equipment and ground-penetrating radar to proactively identify and address hazards. By maintaining these standards, synthetic surfaces can sustain their intended performance and safety benefits over time, reducing injury risks for both horses and riders.
BELOW: Dundalk’s ‘polytrack’ is a wax-coated synthetic surface which is engineered with shock-absorbing properties.





These findings align closely with real-world injury data, such as that collected through the EID, which shows significantly lower rates of injuries and fatalities on synthetic tracks compared to dirt and turf. Peterson’s work further supports this data by demonstrating how the controlled grip, shock absorption, and uniformity of synthetic surfaces mitigate the extreme forces associated with high-speed galloping.
As racing organisations increasingly prioritise equine welfare, integrating these biomechanical insights and maintenance best practices into surface design is becoming essential. This evolution not only addresses safety concerns but also ensures that performance standards are upheld across diverse environmental conditions and yearround racing schedules.
Another pressing challenge tied to track surfaces and horse welfare is the impact of climate change, which is increasingly complicating the maintenance and safety of racing tracks. Extreme weather events, such as heavy rainfall, prolonged droughts, and unexpected temperature fluctuations, threaten the integrity of turf, dirt, and even synthetic surfaces. Maintaining tracks in optimal condition under these conditions is not only a logistical challenge but also critical to equine welfare and the continuity of racing schedules.
Turf tracks, which dominate the European racing landscape, are particularly vulnerable to these climate pressures. Heavy rainfall can waterlog turf, reducing its ability to provide a stable and uniform footing. Prolonged droughts pose a different but equally severe threat.
In 2022, during an exceptionally dry summer, several racecourses in the UK, including Newmarket, faced challenges in maintaining adequate irrigation. The lack of rainfall led to concerns about the firmness of the ground, which can increase the risk of injuries to horses. To address this, racecourses have had to rely heavily on irrigation systems, though these solutions come with significant costs and raise concerns about water sustainability in droughtprone regions.
Dirt tracks, though rare in Europe, face their own set of challenges under extreme weather conditions. Unlike synthetic tracks, dirt surfaces are highly susceptible to changes in moisture levels. Heavy rains can turn dirt tracks into dangerously muddy and slippery courses, increasing the risk of falls and injuries. Even synthetic tracks, while more resilient to climatic variability, are not immune. Extreme heat can affect the surface properties, potentially leading to inconsistent footing. This highlights the need for ongoing innovation in synthetic surface technology to enhance resilience under extreme temperature conditions.
As climate change intensifies, the industry faces an urgent need to adapt its infrastructure and maintenance practices. Investment in weather-resistant technologies, such as hybrid turf systems that combine natural grass with synthetic reinforcement, is one promising avenue. Additionally, many racecourses are exploring more sustainable water use strategies and heat-resistant materials to future-proof their tracks. While these measures require significant financial and operational resources, they are crucial to maintaining the safety and sustainability of horse racing in an increasingly unpredictable climate.
At its core, the quality and maintenance of racing surfaces are fundamental to ensuring the safety and performance of both horses and jockeys. The interaction between a horse’s stride and the track is critical, with every phase: landing, support, and rollover, subjecting the horse’s legs to significant forces that vary depending on the surface type. This makes the choice and upkeep of racing surfaces a cornerstone of the sport.
While turf continues to dominate prestigious events for its tradition, aesthetic appeal, and performance characteristics, synthetic tracks are increasingly recognised for their ability to minimise injury risks, maintain consistency across diverse weather conditions, and meet the demands of year-round racing.
Insights from organisations like The US Jockey Club and BHA, combined with research such as Peterson’s Racing Surfaces White Paper, underline the importance of balancing innovation and tradition in surface design and maintenance. Synthetic surfaces, with their engineered properties, offer uniformity and controlled shock absorption, mitigating the biomechanical stresses that lead to injuries.
However, turf’s natural cushioning and long-standing association with the heritage of the sport ensure its continued dominance at elite racing events. Maintaining this delicate balance is essential to enabling horses and jockeys to perform at their peak while prioritising safety and welfare. As the industry adapts to modern challenges, including climate variability and evolving performance demands, racing surfaces will remain central to ensuring the sport’s longevity and sustainability for future generations.

GMO thoroughbreds? Superhorses created in the lab? Is genetic doping a real “thing”? It’s time for a reality check and a good, hard look at what’s real, or even possible, and how it can hurt or help the thoroughbred industry.

Breeders, trainers and owners continually seek a competitive edge, striving to produce horses with the speed, stamina and resilience needed to succeed on the racetrack. Concurrently, there is increasing pressure and responsibility to minimise animal discomfort, injury and death in a public forum. Therefore we must carefully examine and balance all the tools at our disposal before determining which ones to use and how.
Interestingly, there is a growing technology that may be of more notable controversy than even horse racing: The power of genetics. Perhaps the greatest power man has ever wielded, genetics has sparked numerous debates over the good and evil it can bring. As with most new things, there is a significant fear of the unknown, so how do we even begin to understand it? In short: research, homework and fact-finding. Let’s look at what is fact, scientifically known, and possible today, and then consider what may be possible in the future.
DNA, often called the “blueprint of life,” holds the key to a horse’s inheritance and development, from its physical prowess, size and speed, to temperament and abilities. By studying their genetics, we can unravel the intricate code that dictates the pre-existing traits and characteristics of these powerful athletes. This information can then be utilised in our breeding and performance programs to improve suitability and success, all while upholding ethical standards and preserving the integrity of the sport.
The general rule for Mendelian traits is that a foal inherits one allele from each parent for a given gene. If the inherited alleles are the same, the horse is called homozygous for that gene. If they are different, they are heterozygous. As heterozygosity goes up, genetic diversity is increased, resulting in more variation in the genetic content. This results in a greater adaptability to environmental stressors and change, leading to a more robust animal and population. With equine genetics, we tend to focus on three kinds of genes: Causatives – genes/variants that directly cause a trait or condition, Correlatives – genes/variants that appear alongside, or in common, with a trait or condition and Risks – genes/variants that increase their likelihood/ risk of acquiring that trait or condition.
A thoroughbred study by Momozawa et al. found an association between the dopamine D4 receptor (DRD4) gene and a measure of temperament. In the study, “curiosity”, defined as “an interest in novel objects and a willingness to approach them”, was prevalent in horses with a particular gene variant. Horses preferring to observe carefully, from a distance, were of the opposite variant type, named “vigilance”. Although further research is required, it is not unreasonable to consider that temperament affects a horse's ability to learn, break from the gate, or handle the pressure of large crowds on race day.

Another performance trait, perhaps of more notable interest to thoroughbred enthusiasts is the “speed” gene, myostatin (MSTN). This insertion results in increased muscle growth in horses and other mammals. Genetically, horses can have two copies of the “Sprint” variant, two copies of the “Endurance” variant, or one copy of each, “Sprint/Endurance.” thoroughbreds homozygous for the Sprint variant tend to excel earlier in age, at shorter distances (8 furlongs or less) with quick bursts of speed. Horses homozygous for Endurance excel later, and at longer distances (9 furlongs or more). However, heterozygous horses won at all distances, having both quick bursts of speed and endurance capabilities (Fig. 1).
Speed: Endurance
Temperament: Curious & Vigilant
This horse is genetically Endurance/Endurance, making her more likely to excel at lengths 9 furlongs or greater. She also carries one copy of Vigilance and one copy of Curiosity, which studies indicate may affect her interest in novel objects and willingness to approach them.
Using genome-wide association studies (GWAS), scientists can analyse equine DNA and identify specific genes associated with various health and performance traits. This research holds immense promise, pinpointing genes responsible for desirable traits like speed, temperament, gait, size, and overall health. So how can we use it to produce horses with optimised genetic profiles for racing, while minimising risk and injury? The answer lies within our breeding programs.
Explanation of a thoroughbred’s genetic speed, temperament and genomic inbreeding value.
bloodlines possess underlying genetic traits that express and complement one another. Given science today, the next evolutionary step in this process is to genetically test and confirm the desired traits are present and will be passed on in the most advantageous combinations.
For generations, breeders have been making selections for observed traits, such as pedigree, racing history, prior offspring performance and conformation. Additionally, “Nicking,” the strategic crossing of certain lines with an observed affinity for one another, is another well-known method used to make breeding decisions. These techniques may be successful, as the chosen



Inbreeding (having drastically reduced genetic diversity) poses a significant challenge within the thoroughbred racing industry due to the closed nature of the studbook. Science shows that a 10% increase in inbreeding reduces a horse’s likelihood of successful racing by 7%. Essentially, higher genomic inbreeding correlates with poorer performance. Traditionally, we have relied on pedigree and conformation to make mating decisions. Today, using actual genetics, we can calculate accurate genomic


Breeding the same Sire to two mares may yield foal crops of drastically different inbreeding percentages based upon the original inheritance of the parents.



inbreeding and work towards decreasing it. On paper, two mares (full siblings) would appear to have the same inbreeding value. In reality, they can differ greatly, and if bred to the same stallion, may produce foals with drastically higher or lower enomic inbreeding values (Fig. 2).
Using myostatin again, let’s look at a stallion that, by conformation and pedigree, appears to be the perfect match for your mare. Genetically, the mare is Sprint/Endurance and the stallion is Sprint/Sprint. This would result in a foal who is 50% likely to be Sprint/Endurance and 50% likely to be Sprint/Sprint. Now, if you breed that same mare with a stallion who has, at a minimum, one copy of endurance, the foal would still have a 25% chance of being Sprint/Sprint. However, it would also have a 50% chance of being Sprint/Endurance and a 25% likelihood of being Endurance/Endurance, giving it longer-distance capabilities (Fig. 3).
Beyond discovering performance-related traits, genetic research plays a vital role in promoting the overall health and sustainability of the breed. Health and soundness risks, such as Recurrent Laryngeal Neuropathy (RLN) or “roaring”, Kissing Spines and Tendinopathy are being actively developed as genetically testable variants. Some of these traits can limit a thoroughbred's pre- or post-racing career. Other predispositions, like Chronic Idiopathic Anhidrosis (CIA) or “nonsweater,” or Fracture Risk, can be life-ending if they go undetected.
FIG 3
Mendelian Inheritance of Myostatin, the “Speed Gene”
For simplicity, the insertion is referenced here as “S,” for Sprint, and “E,” for Endurance. This figure shows different foal outcomes, with a homozygous vs heterozygous sire.
Through the use of genetic testing and associated technologies, breeders can “Build-A-Horse” to their specifications by crossing specific sires and dams using confirmed, heritable genetics, that create that optimal foal. By making breeding decisions based on maths and science, we can reduce the presence of undesirable health traits in our programs.
As more thoroughbred owners utilise genetics, collaborating researchers will continue identifying areas of strength and vulnerability in health and performance. This knowledge empowers breeders and buyers to make informed decisions that preserve genetic diversity and ensure the long-term strength of thoroughbred bloodlines. Given the considerable investment of both resources and effort involved in the production and training of horses destined for the track, decreasing risk and increasing financial management is paramount. Remarkably, the cost of utilising genetic testing to ascertain a horse’s optimal race distance is less than one week's feed and can ultimately save owners and breeders both time and money.


As genetic research becomes increasingly integrated into the thoroughbred racing industry, it’s wise to approach this technology with foresight instead of fear. Whilst it offers unprecedented opportunities for improvement and advancement, this research also carries the potential for unintended consequences and ethical dilemmas that must be carefully navigated.
The topic of cloning has been hotly debated in the last decade. The first reaction appears to be to “ban” it in certain registries and competitions. Interestingly, the fears stoked by this technology have not materialised into truth for a seemingly simple reason: You can replicate the genetic code of an animal, but it’s another thing entirely to replicate the uterine environment, the training, feeding, life experiences and competition circumstances.
Another recent concern within the industry is the concept of “gene doping” to create superhorses, which involves artificially modifying an athlete's genes to enhance their performance. For example, the myostatin gene may become the target of genome editing in horses, as it alters the amount and composition of muscle fibre types. Although there are no known foals born, to date, with genetically altered myostatin, could it happen? Maybe. Would the effect be instant in something like myostatin? No. Why? Because that’s not how it works! A live animal has a fully formed physical plan in place, especially for things such as muscle, tendons and bone. Today’s most advanced gene therapies tend to be extremely targeted regions, take months to years to work and are extraordinarily expensive.
Assuming it’s possible to change the myostatin disposition of a horse, could we detect that it was manipulated? The answer, according to multiple experts, is a very strong, “maybe”. Technique and timing would matter as would the simple question of “Could this foal’s parents have passed on this genotype?” As technology advances and provides the opportunity for a competitive edge, it’s safe to say that someone will try it. What then? The answer may just come down to numbers, like everything else on the track.
So, with all of this knowledge, can someone choose a bunch of genetic traits and create a Superhorse? Although you hear about it every day, complex genetic editing is just in its infancy. It is possible to change a gene or variant within an embryo. We’ve been doing it for decades already. So why not a Superhorse? Well…consider the following:
1. It’s not easy to insert a single correct genetic edit that results in a living animal.
2. It takes a large number of iterations and time for that one change.
3. The process can be super expensive. Multiply this by many dollars and much more time for every additional genetic change you wish to add.
4. Once you’ve produced genetic change, now you have to wait years to see the foal perform at which point your choice of changes may no longer be the winning combination!
Although we are likely years away from this being a feasible, let alone common issue, we need to take steps now to understand genetics and devise a reasonable path forward. Preventing the misuse of gene editing could be as simple as creating a standardised genetic testing requirement via hair sample in addition to the standard parentage verification. This initial hair sample would serve as a genetic baseline, offering a comparison for those taken at a later date when genetic modifications are suspected.
By adhering to rigorous standards of ethical conduct, transparency and accountability, we can harness the full potential of genetic research while safeguarding the welfare and integrity of thoroughbred racing.
Genetic research and testing represent a game-changing advancement for the thoroughbred racing industry. It is a powerful tool for enhancing the quality, health and performance of racehorses – all of which are required to maintain the sport's integrity. As we increase our understanding of equine genetics and discover new traits applicable to the thoroughbred, we can produce healthier, more competitive horses, while reducing the historical struggles of inbreeding and breakdown. Although we must be careful to adhere to the ethical code set forth within the industry, by utilising genetics to build the next generation of improved thoroughbreds we can take ownership of the technology and usher in a new era of excellence and innovation within the sport

Sources:
• Hill, E. W., Stoffel, M. A., McGivney, B. A., MacHugh, D. E., & Pemberton, J. M. (2022). Inbreeding depression and the probability of racing in the Thoroughbred horse. Proceedings of the Royal Society B, 289(1977). https://doi.org/10.1098/rspb.2022.0487.
• Momozawa, Y., Takeuchi, Y., Kusunose, R., Kikusui, T., & Mori, Y. (2005). Association between equine temperament and polymorphisms in dopamine D4 receptor gene. Mammalian genome, 16, 538-544. https://doi.org/10.1007/s00335-005-0021-3
• Rooney, M. F., Hill, E. W., Kelly, V. P., & Porter, R. K. (2018). The “speed gene” effect of myostatin arises in Thoroughbred horses due to a promoter proximal SINE insertion. PLoS One, 13(10). https://doi.org/10.1371/journal.pone.0205664
• Tozaki, T., Ohnuma, A., Nakamura, K., Hano, K., Takasu, M., Takahashi, Y., ... & Nagata, S. I. (2022). Detection of indiscriminate genetic manipulation in Thoroughbred racehorses by targeted resequencing for gene-doping control. Genes, 13(9), 1589. https://doi.org/10.3390/genes13091589


















